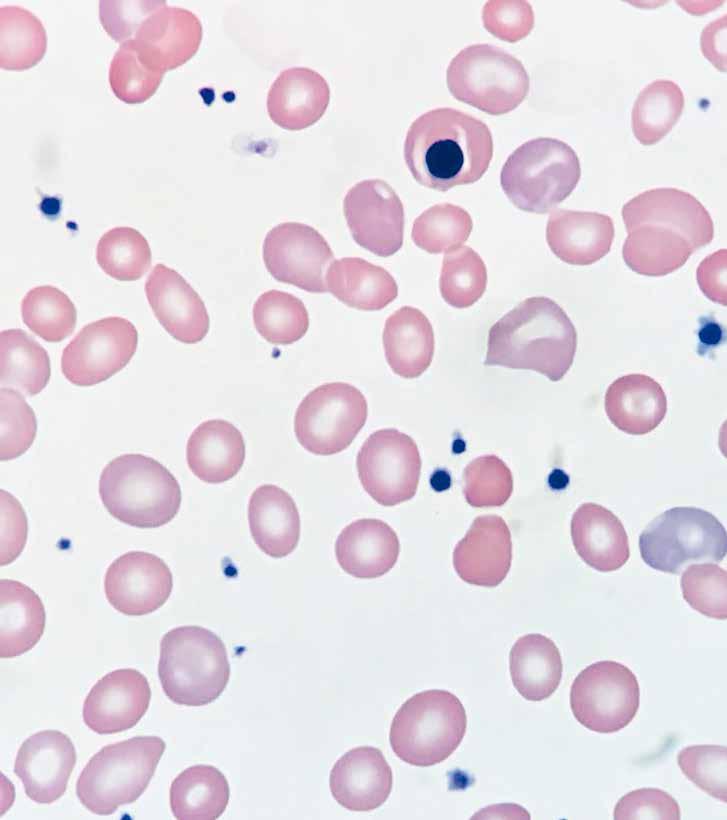

+
REPORTAJE: Hospital Oncológico
Una trayectoria de servicio a pacientes con cáncer en Puerto Rico.
Pág. 28

@BeH ea lt hP R
Escanéa el Código QR y visita la web de BeOncología
Para adultos con CLL/SLL
ELIGE UN FUTURO LIBRE DEL
TRATAMIENTO CONTINUO DE CLL
SOLO los regímenes de VENCLEXTA son LIBRES DE QUIMIO y están diseñados para ser
COMPLETADOS EN 12 MESES
Para CLL / SLL no tratada previamente con VENCLEXTA + GAZYVA® (obinutuzumab)
COMPLETADOS EN ~24 MESES*
Para CLL / SLL previamente tratada con VENCLEXTA + rituximab
Pregúntale a tu médico si VENCLEXTA es adecuado para ti. Su profesional de la salud puede también recetarle VENCLEXTA solo, que se toma hasta que su profesional de la salud le diga que lo suspenda.
*Desde el Ciclo 1, Día 1 de rituximab, después de un aumento de dosis de VENCLEXTA en 5 semanas. CLL- leucemia linfocítica crónica, SLL- linfoma linfocítico de células pequeñas.
Uso
VENCLEXTA es un medicamento recetado usado para tratar a adultos con leucemia linfocítica crónica (CLL, por sus siglas en inglés) o linfoma linfocítico de células pequeñas (SLL, por sus siglas en inglés). No se conoce si VENCLEXTA es seguro y eficaz en niños.
Información Importante de Seguridad
¿Cuál es la información más importante que debo conocer acerca de VENCLEXTA?
VENCLEXTA puede causar efectos secundarios graves, entre ellos:
Síndrome de lisis tumoral (TLS, por sus siglas en inglés). El TLS ocurre a causa del rompimiento rápido de las células de cáncer. El TLS puede causar insuficiencia renal, la necesidad de tratamiento de diálisis y puede conducir a la muerte. Su profesional de la salud le hará pruebas para verificar el riesgo de contraer TLS antes de comenzar a recibir VENCLEXTA. Para ayudar a reducir el riesgo de TLS, recibirá otros medicamentos antes de comenzar y durante el tratamiento con VENCLEXTA. Puede también necesitar recibir líquidos intravenosos (IV) por vena. Su profesional de la salud le hará pruebas para detectar TLS al comenzar su tratamiento y durante el tratamiento con VENCLEXTA. Es importante cumplir con sus citas para las pruebas de sangre. Déjele saber a su profesional de la salud de inmediato si presenta síntomas de TLS durante el tratamiento con VENCLEXTA, incluidos fiebre, escalofríos, náuseas, vómitos, confusión, falta de aliento, convulsiones, latidos del corazón irregulares, orina oscura u opaca, cansancio inusual o dolor muscular o articular.
Beba suficiente agua durante el tratamiento con VENCLEXTA para ayudar a reducir el riesgo de contraer TLS. Beba de 6 a 8 vasos (cerca de 56 onzas en total) de agua todos los días, comenzando 2 días antes de su primera dosis, el día de su primera dosis de VENCLEXTA y cada vez que tenga un aumento de dosis.
Su profesional de la salud puede retrasar, disminuir la dosis o suspender el tratamiento con VENCLEXTA si presenta efectos secundarios. Al volver a comenzar VENCLEXTA después de haberlo suspendido por 1 semana o más, su profesional de la salud puede volver a verificar el riesgo de TLS y cambiarle la dosis
¿Quién no debe tomar VENCLEXTA?
Hay medicamentos específicos que no deben usarse cuando comienza a recibir VENCLEXTA y mientras se aumenta la dosis gradualmente debido al riesgo de TLS.
• Déjele saber a su profesional de la salud de todos los medicamentos que usa, incluidos los recetados y los que no requieren receta, vitaminas y suplementos herbarios. VENCLEXTA y otros medicamentos pueden afectarse unos a los otros y causar efectos secundarios graves.

• No comience a usar un medicamento nuevo durante el tratamiento con VENCLEXTA sin primero consultar con su profesional de la salud. Antes de recibir VENCLEXTA, déjele saber a su profesional de la salud acerca de todos sus padecimientos, incluido si:
• padece de problemas renales o hepáticos.
• presenta problemas con las sales o electrolitos del cuerpo, como potasio, fósforo o calcio.
• tiene antecedentes de niveles de ácido úrico altos en la sangre o gota.
• tiene programado recibir una vacuna. No debe recibir vacunas vivas antes, durante ni después del tratamiento con VENCLEXTA hasta tanto su profesional de la salud le indique que puede hacerlo. Si no está seguro del tipo de inmunización o vacuna, pregunte a su profesional de Visita
VENCLEXTA.com para conocer más.
la salud. Puede que estas vacunas no sean seguras o que no funcionen tan bien durante el tratamiento con VENCLEXTA.
• está embarazada o tiene planes de quedar embarazada. VENCLEXTA puede causarle daño al feto. Si tiene la capacidad para quedar embarazada, su profesional de la salud debe hacerle una prueba de embarazo antes de comenzar el tratamiento con VENCLEXTA, y debe usar un método de control del embarazo efectivo durante el tratamiento y por 30 días después de la última dosis de VENCLEXTA. Si queda embarazada o cree que puede estar embarazada, déjeselo saber a su profesional de la salud de inmediato.
• está lactando o tiene planes de lactar. No se conoce si VENCLEXTA pasa a la leche materna. No debe lactar durante el tratamiento con VENCLEXTA y por 1 semana después de la última dosis.
¿Qué debo evitar mientras tomo VENCLEXTA?
No debe beber jugo de toronja, ni comer toronja, naranjas (chinas) de Sevilla (a menudo usadas en mermeladas), ni carambola mientras toma VENCLEXTA. Estos productos pueden aumentar la cantidad de VENCLEXTA en la sangre.
¿Cuáles son los efectos secundarios posibles de VENCLEXTA?
VENCLEXTA puede causar efectos secundarios graves, entre ellos:
• Recuentos bajos de glóbulos blancos (neutropenia). Los recuentos bajos de glóbulos blancos son comunes con VENCLEXTA, pero también pueden ser graves. Su profesional de la salud le hará pruebas para verificar los recuentos sanguíneos durante el tratamiento con VENCLEXTA y pudiera interrumpir la dosificación.
• Infecciones. Han ocurrido muertes e infecciones graves, como neumonía e infecciones sanguíneas (septicemia), durante el tratamiento con VENCLEXTA. Su profesional de la salud lo vigilará de cerca y le brindará tratamiento de inmediato si presenta fiebre o cualquier signo de infección durante el tratamiento con VENCLEXTA.

Déjele saber a su profesional de la salud de inmediato si presenta fiebre o algún signo de infección durante el tratamiento con VENCLEXTA. Los efectos secundarios más frecuentes de VENCLEXTA cuando se utiliza en combinación con obinutuzumab o rituximab o solo en personas con LLC o SLL incluyen recuentos bajos de glóbulos blancos; recuentos bajos de plaquetas; recuentos bajos de glóbulos rojos; diarrea; náuseas; infección de las vías respiratorias superiores; tos; dolor muscular y articular; cansancio; e hinchazón de brazos, piernas, manos y pies.
VENCLEXTA puede causar problemas de fertilidad en varones. Esto puede afectar su capacidad para engendrar un hijo. Hable con su profesional de la salud si le preocupa la fertilidad.
Estos no son todos los efectos secundarios posibles de VENCLEXTA. Para obtener más información, consulte a su proveedor de atención médica o a su farmacéutico.
Se le exhorta a notificar los efectos secundarios de los medicamentos recetados a la FDA. Acceda a www.fda.gov/medwatch o llame al 1-800FDA-1088.
Si no puede pagar por su medicamento, comuníquese con genentechaccess.com/patient/brands/venclexta para asistencia.
Vea las páginas siguientes para un Breve Resumen de la Información sobre Prescripción.
GAZYVA®
No se conoce si VENCLEXTA es seguro y eficaz en niños. Representación de un actor
© 2022 AbbVie y Genentech USA, Inc. Todos los derechos reservados. VENCLEXTA® y su diseño son marcas registradas de AbbVie Inc.
y su diseño son marcas registradas de Genentech, Inc.
US-VENC-210220 Junio 2022
VENCLEXTA® (ven-KLEKS-tuh) (comprimidos de venetoclax)
Información para el paciente
¿Cuál es la información más importante que debo saber acerca de VENCLEXTA?
VENCLEXTA puede provocar efectos secundarios graves, incluido:
• Síndrome de lisis tumoral (Tumor Lysis Syndrome, TLS). El TLS se debe a la descomposición rápida de las células cancerosas. El TLS puede provocar insuficiencia renal, la necesidad de tratamiento con diálisis y puede ocasionar la muerte. Su proveedor de atención médica realizará análisis para controlar el riesgo de tener TLS antes de que comience a tomar VENCLEXTA. Recibirá otros medicamentos antes de comenzar el tratamiento con VENCLEXTA y durante este para ayudarlo a reducir el riesgo de TLS. Es posible que también reciba líquidos intravenosos (i.v.) en la vena. Su proveedor de atención médica realizará análisis de sangre para detectar si hay TLS cuando inicie el tratamiento por primera vez y durante el tratamiento con VENCLEXTA. Es importante que cumpla con sus citas para los análisis de sangre. Indique a su proveedor de atención médica de inmediato si tiene síntomas de TLS durante el tratamiento con VENCLEXTA, incluidos:
• fiebre
• escalofríos
• náuseas
• vómitos
• confusión
• dificultad para respirar
• convulsiones
• latidos cardíacos irregulares
• orina oscura o turbia
• cansancio inusual
• dolor muscular o articular
Beba abundante agua durante el tratamiento con VENCLEXTA para ayudar a reducir el riesgo de tener TLS
Beba de 6 a 8 vasos (alrededor de 56 onzas en total) de agua por día, comenzando 2 días antes y en el día de su primera dosis de VENCLEXTA, y cada vez que se aumente la dosis.
Su proveedor de atención médica puede demorar, disminuir su dosis o suspender el tratamiento con VENCLEXTA si usted tiene efectos secundarios. Cuando se reinicie la administración de VENCLEXTA después de haber interrumpido 1 semana o más, su proveedor de atención médica puede volver a comprobar su riesgo de TLS y cambiar su dosis.
Consulte “¿Cuáles son los posibles efectos secundarios de VENCLEXTA?” para obtener más información sobre los efectos secundarios.
¿Qué es VENCLEXTA?
VENCLEXTA es un medicamento, de venta con receta, que se usa:
• Para tratar adultos con leucemia linfocítica crónica (chronic lymphocytic leukemia, CLL) o linfoma linfocítico de células pequeñas (small lymphocytic lymphoma, SLL).
• En combinación con azacitidina o decitabina, o citarabina en dosis bajas para tratar adultos con leucemia mieloide aguda (Acute Myeloid Leukemia, AML) de diagnóstico reciente que:
• tienen 75 años de edad o más, o
RESUMEN PARA EL CONSUMIDOR
Consulte el prospecto del envase para ver la información sobre la Prescripción completa
Lea la Guía del medicamento que viene con VENCLEXTA antes de empezar a utilizarlo y cada vez que vuelva a surtir la receta. Es posible que haya nueva información. Este resumen no es completo y no reemplaza la conversación con su médico sobre su condición médica o tratamiento. Para obtener una copia completa de la Información de prescripción, visite www.VENCLEXTA.com o llame al 1-800-633-9110.
• padecen otras afecciones médicas que impiden el uso de quimioterapia estándar. Se desconoce si VENCLEXTA es seguro y eficaz en niños.
¿Quién no debe tomar VENCLEXTA?
No se deben tomar ciertos medicamentos cuando comienza a recibir VENCLEXTA ni mientras se aumenta lentamente la dosis, debido al riesgo de aumento del síndrome de lisis tumoral (TLS).
• Informe a su proveedor de atención médica acerca de todos los medicamentos que usa, incluidos los de venta con receta y de venta libre, vitaminas y suplementos a base de hierbas. VENCLEXTA y otros medicamentos pueden interactuar entre sí y causar efectos secundarios graves.
No empiece a tomar medicamentos nuevos durante el tratamiento con VENCLEXTA sin hablar primero con su proveedor de atención médica.
Antes de tomar VENCLEXTA, informe a su proveedor de atención médica acerca de todas sus afecciones médicas, incluso si usted:
• tiene problemas renales
• tiene problemas hepáticos
• tiene problemas con las sales corporales o los electrolitos, como potasio, fósforo o calcio
• tiene antecedentes de niveles de ácido úrico alto en sangre o gota
• tiene programado recibir una vacuna. No debe recibir una “vacuna con virus vivos” antes, durante ni después del tratamiento con VENCLEXTA, hasta que su proveedor de atención médica se lo autorice. Si no está seguro sobre el tipo de inmunización o vacuna, pregunte a su proveedor de atención médica. Es posible que estas vacunas no sean seguras o no funcionen tan bien durante el tratamiento con VENCLEXTA.
• Si está embarazada o planea quedar embarazada. Es posible que VENCLEXTA cause daño al feto.
• Si puede quedar embarazada, su proveedor de atención médica debe realizarle una prueba para la detección del embarazo antes de iniciar el tratamiento con VENCLEXTA.
• Las mujeres que pueden quedar embarazadas deben usar un método anticonceptivo eficaz durante el tratamiento y por 30 días después de la última dosis de VENCLEXTA.
• Informe a su proveedor de atención médica de inmediato si queda embarazada o piensa que está embarazada.
• Si está amamantando o planea amamantar. No se sabe si VENCLEXTA pasa a la leche materna. No amamante durante el tratamiento ni durante 1 semana después de la última dosis de VENCLEXTA.
Informe a su proveedor de atención médica acerca de todos los medicamentos que usa, incluidos los de venta con receta y de venta libre, vitaminas y suplementos a base de hierbas. VENCLEXTA y otros medicamentos pueden interactuar entre sí y causar efectos secundarios graves. Consulte “¿Quién no debe tomar VENCLEXTA?”.
¿Cómo debo tomar VENCLEXTA?
• Tome VENCLEXTA exactamente como se lo indique su proveedor de atención médica. No cambie su dosis de VENCLEXTA ni deje de tomar VENCLEXTA, a menos que su proveedor de atención médica se lo indique.
• Cuando tome por primera vez VENCLEXTA:
• Es posible que necesite tomar VENCLEXTA en el hospital o en la clínica para monitorear el TLS.
• Si está tomando VENCLEXTA para la CLL o para el SLL, su proveedor de atención médica iniciará la administración de VENCLEXTA en una dosis baja. Su dosis se aumentará lentamente una vez por semana durante 5 semanas hasta llegar a la dosis completa. Lea la Guía rápida de inicio que viene con VENCLEXTA antes de la primera dosis.
• Si está tomando VENCLEXTA para la AML, su proveedor de atención médica iniciará la administración de VENCLEXTA en una dosis baja. Su dosis se aumentará lentamente a diario hasta llegar a la dosis completa. Siga cuidadosamente las instrucciones de su proveedor de atención médica durante el aumento hasta la dosis completa.
• Siga las instrucciones sobre tomar agua descritas en la sección de este resumen sobre el TLS llamada “¿Cuál es la información más importante que debo conocer acerca de VENCLEXTA?” y también en la Guía rápida de inicio.
• Tome VENCLEXTA 1 vez al día con una comida y agua aproximadamente a la misma hora todos los días.
• Trague los comprimidos de VENCLEXTA enteros. Los comprimidos no se deben masticar, triturar ni partir.
• Informe a su proveedor de atención médica si tiene problemas para tragar comprimidos de 100 mg de VENCLEXTA. Su proveedor de atención médica puede recetarle la dosis en comprimidos más pequeños.
• Si omite una dosis de VENCLEXTA y han pasado menos de 8 horas, tome su dosis tan pronto como sea posible. Si omite una dosis de VENCLEXTA y han pasado más de 8 horas, salte la dosis omitida y tome la dosis siguiente en el horario habitual.
• Si vomita después de tomar VENCLEXTA, no tome ninguna dosis adicional. Tome la siguiente dosis en el horario habitual al día siguiente.
¿Qué debo evitar mientras tomo VENCLEXTA?
No debe beber jugo de toronja, comer toronjas, naranjas de Sevilla (generalmente en mermeladas) o carambolas mientras toma VENCLEXTA. Estos productos pueden aumentar la cantidad de VENCLEXTA en la sangre.
DO NOT RE-SIZE US-VENC-210220
¿Cuáles son los posibles efectos secundarios de VENCLEXTA?
VENCLEXTA puede provocar efectos secundarios graves, incluido:
• Consulte “¿Cuál es la información más importante que debo saber acerca de VENCLEXTA?”
• Recuento bajo de glóbulos blancos (neutropenia). Los recuentos bajos de glóbulos blancos son frecuentes con VENCLEXTA, pero también pueden ser graves. Su proveedor de atención médica hará análisis de sangre para controlar sus recuentos sanguíneos durante el tratamiento con VENCLEXTA y puede interrumpir temporalmente la dosis.
• Infecciones. Se han producido muertes e infecciones graves, como neumonía e infección sanguínea (septicemia), durante el tratamiento con VENCLEXTA. Su proveedor de atención médica lo monitoreará atentamente y lo tratará de inmediato si tiene fiebre o algún signo de infección durante el tratamiento con VENCLEXTA. Informe a su proveedor de atención médica de inmediato si tiene fiebre o algún signo de una infección durante el tratamiento con VENCLEXTA. Los efectos secundarios más frecuentes de VENCLEXTA cuando se usa en combinación con obinutuzumab o rituximab, o solo, en personas con CLL o SLL incluyen los siguientes:
• recuento bajo de plaquetas
• recuento bajo de glóbulos rojos
• diarrea
• náuseas
• infección de las vías respiratorias superiores
• tos
• dolor muscular y articular
• cansancio
• hinchazón de los brazos, las piernas, las manos y los pies
Los efectos secundarios más frecuentes de VENCLEXTA en combinación con azacitidina o decitabina o citarabina en dosis bajas en personas con AML incluyen los siguientes:
• náuseas
• diarrea
• recuento bajo de plaquetas
• recuento bajo de plaquetas
• estreñimiento
• recuento bajo de glóbulos blancos
• fiebre con recuento bajo de glóbulos blancos
• cansancio
• vómitos
• hinchazón de los brazos, las piernas, las manos o los pies
• fiebre
• infección en los pulmones
• infección en la sangre
• dolor muscular y articular
• mareos
• tos
• dolor de garganta
• presión arterial baja
¿Cuáles son los ingredientes de VENCLEXTA?
Principio activo: venetoclax
Principios inactivos: copovidona, dióxido de silicio coloidal, polisorbato 80, fumarato estearil de sodio y fosfato de calcio dibásico.
• dificultad para respirar
• sangrado
• recuento bajo de glóbulos rojos
• sarpullido
• dolor estomacal (abdominal)
VENCLEXTA puede provocar problemas de fertilidad en los hombres. Esto puede afectar su capacidad de engendrar un hijo. Informe a su proveedor de atención médica si tiene inquietudes sobre la fertilidad.
Estos no son todos los efectos secundarios posibles de VENCLEXTA. Llame a su médico para recibir asesoramiento médico acerca de los efectos secundarios. Puede informar los efectos secundarios a la Administración de Alimentos y Medicamentos (Food and Drug Administration, FDA) llamando al 1-800-FDA-1088.
¿Cómo debo almacenar VENCLEXTA?
• Almacene VENCLEXTA a 86 °F (30 °C) o menos.
• Conserve VENCLEXTA en su envase original para protegerlo de la humedad.
• En el caso de las personas con CLL o SLL, conserve los comprimidos de VENCLEXTA en el envase original durante las primeras 4 semanas del tratamiento. No transfiera los comprimidos a otro envase.
Mantenga VENCLEXTA y todos los medicamentos fuera del alcance de los niños.
Información general sobre el uso seguro y eficaz de VENCLEXTA.
A veces, los medicamentos se recetan con fines que no son los detallados en la Guía del medicamento. No utilice VENCLEXTA para tratar una enfermedad para la que no fue recetado. No administre VENCLEXTA a otras personas aunque tengan los mismos síntomas que usted. Podría causarles daño. Puede pedirle a su farmacéutico o a su proveedor de atención médica información sobre VENCLEXTA publicada para profesionales de la salud.
Los comprimidos recubiertos de 10 mg y 100 mg contienen lo siguiente: óxido de hierro amarillo, alcohol polivinílico, polietilenglicol, talco y dióxido de titanio. Los comprimidos recubiertos de 50 mg también contienen lo siguiente: óxido de hierro amarillo, óxido de hierro rojo, óxido de hierro negro, alcohol polivinílico, talco, polietilenglicol y dióxido de titanio.
Fabricado y comercializado por:
AbbVie, Inc.
North Chicago, IL 60064
© 2016-2022
AbbVie Inc.
Comercializado por:
Genentech USA, Inc.
Un miembro del Grupo Roche
South San Francisco, CA 94080-4990
© 2016-2022
Genentech, Inc.
Se le recomienda informar a la FDA los efectos secundarios negativos de los fármacos de venta con receta. Visite www.fda.gov/medwatch o llame al 1-800-FDA-1088.
Si no puede pagar sus medicamentos, comuníquese con genentech-access.com/patient/brands/ venclexta para obtener ayuda.
Ref.: 20070720 Revisado: Junio 2022
LAB-7541 VERSIÓN MAESTRA EN INGLÉS
LAB-7544 VERSIÓN MAESTRA EN ESPAÑOL
US-VENC-210220
DO NOT RE-SIZE US-VENC-210220
Qué está pasando con los cánceres sanguíneos en Puerto Rico: expertos opinan
Evalúan opciones de tratamiento quirúrgico para pacientes con cáncer colorrectal

20 22 26
De reina de belleza a guerrera contra el cáncer: La historia inspiradora de Karina
Manejo del cáncer de pulmón en Puerto Rico: ¿cuál es la situación actual?
La mielodisplasia y sus implicaciones en la salud: Una visión experta con la Dra. Anna Di Marco
18 32 44 50 58
Mieloma múltiple: signos de alerta y alternativas para mejorar la condición
Silverio Pérez: Más allá del humor, una historia de lucha y superación contra el cáncer de próstata
Estilo de vida y nutrición en el paciente con cáncer gástrico
6 www.behealthoncologia.com
CONTENIDO
Sobrevivir al cáncer:
 Por: Jessica López Santiago RN, MSN, CON, BCCN Enfermera Oncóloga
Por: Jessica López Santiago RN, MSN, CON, BCCN Enfermera Oncóloga
La enfermería oncológica es una rama de la profesión que conduce al tratamiento y cuidado de los pacientes con cáncer, una enfermedad que requiere de ciencias muy delimitadas, por lo que los profesionales desarrollados en el área son de alta envergadura y demanda.
Los profesionales de la salud que se especializan en esta área adquieren una capacitación teórica y práctica a nivel holístico encerrando todo lo necesario para satisfacer las necesidades de los pacientes oncológicos, que son tanto físicas, sociales, espirituales como emocionales.
Es una de las especialidades de enfermería más completa e importante del gremio, dado al alto crecimiento de esta condición en la población. Por ejemplo, en Puerto Rico se reportaron alrededor de 13,300 casos nuevos de cáncer, 53% en hombres y 47% en mujeres, posicionando el cáncer como la segunda causa de muerte en el país y causante del mayor número de muertes prematuras en Puerto Rico. Esto crea una necesidad apremiante en el sistema de salud de necesitar profesionales capacitados, pues el rol de enfermería en pacientes oncológicos es acompañar al paciente y a los cuidadores durante todas las etapas de la enfermedad a un nivel profesional e integral.
Ser enfermero oncólogo es un arte convergiendo con la ciencia y el humanismo, afinado con la experiencia y las capacitaciones continuas para cumplir con las funciones que normalmente se requieren durante el proceso del cáncer. Y es que, la enfermería es una ciencia y arte milenario fundamentado en una teoría reciente, donde el personal de enfermería oncológica demuestra sus conocimientos teóricos, clínicos y humanos a través de la práctica dando esperanza, cuidados de calidad y una mano amiga que guía al paciente y familiares.
Como profesional de la salud es un honor para mí ser parte de esta nueva publicación de BeHealth en la que, al igual que la profesional del enfermero oncólogo, convergen historias de vida, aspectos clínicos de las enfermedades y el importante componente de la salud mental.
Ileana Santiago, M.B.A. Lic. R-726 | CEO

Ingerny Polanco | Comunicaciones Corporativas

Marcela Castro | Directora Creativa y desarrollo de marca de BeHealth Business
Alejandra González | Jefa de Redacción Digital Patricio Domínguez | CDO
José Manuel Fiallo | Diseñador Gráfico & Multimedios
Rosmery Cernadas | Editora
Anaeli Santiago | Diseñadora Gráfica & Multimedios
Lina Pérez | Diseñadora Gráfica & Multimedios
Edgardo García | Producción & Diseñador Multimedios
Christian Reyes | Editor Audiovisual
Paola Vélez | Periodista Multimedios
Amanda Marcolin | Analista Digital
Alejandra Montenegro | Editora Audiovisual
Yakish Quintana | Community Liaison
Julie Gotay & Glorily Santiago | Administración
Para comunicarse con nosotros puede hacerlo a través de info@behealthpr.com

Todos los derechos reservados ®2023, Prohibida su reproducción total o parcial sin autorización.

Copyright © 2023 – BeHealth Business

Escucha nuestros episodios y aprende a cuidar tu salud a través de la experiencia de médicos, pacientes, cuidadores y personalidades inspiradoras.
¡Escanea el código! EQUIPO DE TRABAJO
¿Quieres aprender a tomar el control de tu salud?
Es un camino que recorremos junto a ti
¿QUÉ ES EL CÁNCER?
El cáncer es una enfermedad donde algunas células del cuerpo se multiplican sin control y se diseminan a otras partes del cuerpo.
Existen más de 200 tipos de cáncer. Cada uno de ellos posee características particulares, que en algunos casos son completamente diferentes al resto de los otros cánceres, con sus causas, su evolución y su tratamiento específico.
LOS TIPOS DE CÁNCER
MÁS COMUNES SON:

Cáncer de mama
Cáncer de pulmón



cáncer colorrectal
Cáncer de próstata






Linfoma no Hodgkin
Cáncer de tiroides
Leucemia



FACTORES DE RIESGO
Edad: es más frecuente en personas mayores de 65 años.
Antecedentes familiares: si el cáncer es frecuente en tu familia es posible que las mutaciones pasen de una generación a la siguiente.
Hábitos: fumar, beber alcohol en exceso y la obesidad aumentan el riesgo de cáncer.
Entorno: sustancias químicas perjudiciales y el humo de segunda mano pueden aumentar el riesgo de cáncer.
El cáncer es la segunda causa de muerte en el mundo. Sin embargo, las tasas de supervivencia están aumentando en el caso de muchos tipos de cáncer, gracias a los avances en los exámenes de detección,los tratamientos y la prevención.
Fuentes: American Cancer Society, Mayo Clinic, NIH, OMS.

cáncer en Puerto Rico
Los más comunes son:
TIROIDES



COLORRECTAL
Según las estadísticas del Registro de Cáncer, la edad promedio de diagnóstico de enfermedades oncológicas es 66 años, dónde el grupo mayor de prevalencia es el de 65 a 79 años y en el que los niños tienen una incidencia del 1%.
En las mujeres el cáncer más común es el cáncer de seno.
En los niños el cáncer más frecuente es la leucemia.
Los hombres se ven afectados principalmente por el cáncer de próstata.
Estudios del Observatorio Global de Cáncer por la OMS
Se registraron 13,080 nuevos casos de cáncer en Puerto Rico de los cuales 5,570 fallecieron para el año 2020.
Hablemos del
BREAST Awareness Month CANCER OCTOBER
PRÓSTATA
PULMÓN
SENO
Cuando se enfrenta un diagnóstico de cáncer es comprensible experimentar una montaña rusa de emociones debido a las decisiones que se deben tomar sobre el tratamiento y el impacto que esto tiene en las vidas. Este agotamiento mental y emocional puede debilitarte en un momento en el que es importante encontrar un equilibrio y conectarte con la fuerza que tienes dentro.
¿Qué puede hacer el mindfulness por ti? Comencemos por definirlo. Practicar la atención plena o vivir en el momento presente evitará que la mente se vaya al futuro, imaginando los peores escenarios o tratando de resolver todos los problemas que puedan surgir a raíz del diagnóstico. Es completamente normal sentir miedo, coraje, ansiedad y tristeza, pero vivir en el momento te ayudará a reconocer esas emociones, manejarlas y aceptarlas sin identificarte plenamente con ellas.

10 www.behealthoncologia.com
El poder transformador del Mindfulness ante el diagnóstico de cáncer
Dejar que la mente se proyecte al futuro solo generará ansiedad, al igual que vivir en el pasado siempre nos traerá tristeza. Ni el futuro ni el pasado existen realmente. Lo único que tienes es el hoy... Y el hoy está lleno de esperanza si lo permites.
Algunos piensan que vivir en el presente es demasiado difícil o incluso imposible. Sin embargo, la mente aprende y se transforma constantemente, y podemos entrenarla fácilmente para traerla de vuelta al presente cuando nos demos cuenta de que se está escapando. ¿Cómo sabemos cuándo se escapa? Cuando sentimos ese miedo, esa ansiedad o esa tristeza que nos abruman. En ese momento, detente, respira, inhala y exhala lentamente, y recuerda en qué tiempo y espacio te encuentras. Pregúntate: “¿Qué estoy sintiendo en este momento?” y “¿Qué ocurrió o en qué estaba pensando para sentirme así?” Este es un buen primer paso para conocer nuestra mente y cómo se comporta.
Continúa respirando y desarrolla compasión hacia ti mismo en estos momentos. No estoy hablando de sentir lástima por ti, la compasión es algo diferente... es darse la oportunidad de llorar, de sentir, de no tomar decisiones de inmediato, de pedir a los demás que necesitan estar solos por un rato. Vivir en mindfulness nos ayuda a desarrollar el autoconocimiento y a no exigirnos demasiado durante este proceso de diagnóstico y tratamiento del cáncer.
Puedes utilizar situaciones cotidianas para recordarte estar presente y evaluar cómo te encuentras mental y emocionalmente. Por ejemplo, mientras te lavas los dientes o te bañas, concéntrate en lo que está sucediendo en ese momento y trata de describir mentalmente las sensaciones que estás experimentando. Aunque pueda parecer una práctica insignificante, en realidad te estás anclando en el presente, ya que normalmente nuestra mente divaga y pensamos en muchas cosas mientras nos bañamos, fregamos o nos cepillamos los dientes. No estamos presentes.
Es posible que pienses que estar presente con tu cáncer, tus emociones y tus sentimientos te causará más sufrimiento. Puede que creas que es mejor escapar. Pero en realidad, estar presente con tu miedo, tu dolor, tu incomodidad y los efectos secundarios del tratamiento es hacer las paces con el proceso emocional y físico que estás atravesando, y eso siempre resultará en liberación.
Practica vivir en el presente, en la atención plena, en el mindfulness en cada minuto de tu vida. Enfócate en la actividad que estás realizando en ese momento, ya sea comer, bailar, caminar o recibir quimioterapia u otro tratamiento. Está presente allí. Poco a poco, encontrarás un mayor equilibrio, bienestar y alegría, incluso en medio de algo tan difícil como esto. Toma un día a la vez. Lily
11 @BeH ea lt hP R
García
Por:Mariliana Torres, Ph.D.
Fernando Cabanillas Escalona es un reconocido médico puertorriqueño, investigador, humanista y fiel creyente en la justicia social. Como director del Centro de Cáncer del Hospital Auxilio Mutuo, en San Juan, ha logrado posicionarse como figura clave en investigaciones del cáncer con aportaciones vitales para los pacientes. Por ejemplo, si nos referimos a la pandemia del coronavirus, por covid-19 en Puerto Rico, utilizó efectivamente sus diversas plataformas comunicacionales para educar, calmar y concienciar.
Dr. Fernando Cabanillas: Gigante de la investigación oncológica

Recientemente recibió el premio “Giants or Cancer Care” en la categoría de Linfoma, un prestigioso galardón que se otorga a líderes mundiales en el campo de la oncología para reconocer las aportaciones en la investigación y el manejo de pacientes con cáncer. Al hablar con Cabanillas Escalona, destacó el premio y lo equiparó a “cuando los peloteros logran entrar al salón de la fama del béisbol. Es un honor acompañar a otros médicos”. Honor a quien merece por sus aportaciones y ejecutorias.
Reflexionando sobre su carrera dijo no arrepentirse de haber seleccionado la medicina como su norte profesional y académico dado que también es catedrático del Recinto de Ciencias Médicas de la Universidad de Puerto Rico. “Decidí ser médico cuando una monja del colegio donde estudiaba me abrió los ojos. Cuando estudiaba en escuela secundaria en el Perpetuo Socorro mi intención era estudiar leyes, pero una monja, Sister María de la Cruz, me abrió los ojos y me dijo, ‘¿por qué leyes si te gusta tanto la ciencia?’”.
El doctor Cabanillas Escalona es un apasionado de la investigación por lo que no vislumbra el retiro. “Me ilusiona mucho continuar investigando”, apuntó.
“Giants of Cancer Care”, precisamente, distingue su aportación sobresaliente en la investigación y el manejo de pacientes con cáncer, cuyos descubrimientos han ayudado a mejorar la calidad de vida de pacientes con la enfermedad. Cabanillas Escalona es parte del grupo de 12 galardonados de diversas categorías de la lucha contra el cáncer, que fueron elegidos entre cientos de oncólogos de todo el mundo. Cabe destacar que el galeno puertorriqueño es uno de los mejores investigadores en la disciplina de la medicina del mundo. “Este premio es un extraordinario honor que acepto con emoción y humildad, y que dedicó a Puerto Rico”, dijo el médico.
Cabanillas Escalona plantea la prevención como responsabilidad social al enfatizar que cada paciente debe someterse a pruebas de cernimiento. Aconseja, además, evitar el sobrepeso y la obesidad debido a que predisponen el riesgo de cáncer. En Puerto Rico, según el doctor, están aumentando el número de pacientes con cáncer de colon; por eso, el doctor aconseja que cada persona desde los 45 años “se hagan las pruebas necesarias”. La prevención ayuda a detectar pólipos precancerosos.
12
www.behealthoncologia.com
Dr. Fernando Cabanillas Hematólogo-Oncólogo y Director del Centro de Cáncer del Hospital Auxilio Mutuo
En cuanto a los problemas que la clase médica tiene en Puerto Rico con las aseguradoras (planes de cobertura médica) dijo sentirse preocupado por la cantidad de colegas que deciden irse al no tener otra opción ya que le “están cerrando la red, es decir, no le dan contrato a médicos nuevos y esto está causando que los médicos se vayan”. Como el problema es mayor de lo que se ha mencionado públicamente Cabanillas Escalona instó a identificar y revelar los nombres de los legisladores que reciben dinero de las aseguradoras como se ha hecho en Texas, Estados Unidos.
Cabanillas Escalona estudió Biología en la Universidad de Puerto Rico, Recinto de Río Piedras, de donde se graduó en 1966. Cuatro años después, obtuvo su doctorado en Medicina del Recinto de Ciencias Médicas de la UPR. Inició sus estudios en Hematología oncológica en el Hospital Universitario de San Juan, para luego completarlos en Houston.
Trabajó en el Centro de Cáncer MD Anderson de la Universidad de Texas donde dirigió el departamento de linfoma/mieloma. Regresó en el 2002 a Puerto Rico para desarrollar y dirigir el Centro de Cáncer del Hospital Auxilio Mutuo.
Ha ganado reputación internacional con sus investigaciones clínicas sobre el desarrollo de varias combina-

ciones efectivas de quimioterapia para tratar linfomas en recaída y estableció un sistema para predecir los resultados del tratamiento de linfoma. Sus hallazgos han contribuido al desarrollo de terapias curativas para los linfomas de grado bajo.
Entre sus reconocimientos ha recibido la “Medalla de Plata de la Sociedad de Medicina Oncológica de Sudáfrica”; el premio de “Distinguished Faculty Achievement”, en 1994, del Centro de Cáncer MD Anderson; fue “Profesor del Año 2002” en la Universidad de Texas en el Centro de Cáncer MD Anderson, y ha sido distinguido por varios años como “Best Doctors in America”. En el 2009, además, recibió el premio Gerald P. Bodey, también del Centro de Cáncer MD Anderson en Houston. En el 2014 le dedicaron la convención anual de la Sociedad de Médicos Graduados de la Escuela de Medicina de la Universidad de Puerto Rico.
Su pasión por la medicina no lo aparta de defender causas sociales y políticas por lo cual dirigió actividades para reclamar al Gobierno de Estados Unidos la aprehensión del ex preso político puertorriqueño Oscar López Rivera, quien fue liberado en el 2017 luego de 35 años en prisión. Sin miedo a exteriorizar sus convicciones, Cabanillas Escalona identifica el estatus político colonial como la causa fundamental de todos los problemas que afectan a Puerto Rico.
13 @BeH ea lt hP R
Si hay alguien en Puerto Rico que sea reconocido como un abanderado en la lucha contra el cáncer, ese es el Dr. Alexis Cruz Chacón. Con una amplia carrera en hematología-oncología, el doctor trabaja incansablemente para ayudar a los pacientes que padecen esta enfermedad.

Por: Redacción BeHealth
Alexis Cruz Chacón, uno de los abanderados contra el cáncer en Puerto Rico
En BeHealth decidimos resaltar la trayectoria del Dr. Cruz Chacón y tuvimos la oportunidad de conocer de primera mano cómo se adentró en el campo de la oncología, sus desafíos, sus misiones y hasta cuándo planea retirarse.
“Escogí especializarme en hematología-onco logía porque considero que es uno de los cam pos más gratificantes de la medicina. No solo es interesante y representa un gran desafío, sino que sobre todo brinda una gran satisfacción al ofrecer a uno como médico la oportunidad de marcar la diferencia en la vida de un paciente”, enfatizó el doctor.
Los logros
El Dr. Cruz Chacón desempeña el cargo de director del Programa de Terapia Celular y Trasplante de Sangre y Médula en el Hospital Español Auxilio Mutuo, y desde allí ha obtenido numerosos logros en el campo de la oncología. ¿Cuáles son algunos de estos logros?
“En el área de trasplante de médula ósea estamos trabajando arduamente para implementar la terapia celular en Puerto Rico. Esta es una meta
14
www.behealthoncologia.com
Dr. Alexis Cruz Chacón Hematólogo Oncólogo
que nos hemos propuesto y estamos dedicados a alcanzar ”, resaltó el especialista.
Además, uno de sus objetivos es “desarrollar la investigación en el ámbito del trasplante de médula ósea y la terapia celular” , a través de nuevos protocolos y estudios clínicos, con el fin de “ampliar aún más las opciones de tratamiento disponibles para los pacientes”.
El Dr. Cruz también colabora en el Hospital Municipal de San Juan, donde ha logrado importantes avances en beneficio de la población oncológica. Algunos de estos
“Tenemos un proyecto para aumentar la disponibilidad de estudios clínicos en la isla para pacientes con cánceres sanguíneos, como leucemia aguda, mieloma múltiple y síndrome mielodisplásico. Estas son condiciones en las cuales los tratamientos disponibles no son ideales, y precisamente en ese tipo de situaciones los estudios clínicos brindan a los pacientes la oportunidad de acceder a tratamientos más efectivos y les dan esperanza”, destacó el doctor.
Los objetivos del doctor

El Dr. Cruz Chacón encuentra motivación en diversas causas, como formar nuevos médicos y contribuir al tratamiento del cáncer, entre muchas otras luchas. Desde su amplia experiencia busca seguir aportando en diversos ámbitos.
“Le apuesto también a todos estos jóvenes médicos que se están formando en nuestra isla. Confío en que puedan seguir desarrollando el campo de la medicina y llevarlo al nivel que nuestros pacientes merecen” , afirmó.
Además, aprovechó la oportunidad para dirigir un mensaje a los médicos en formación, instándolos a continuar con su labor. “Mi compromiso consiste en proporcionarles las herramientas necesarias para que, en el futuro, cuando ya no podamos trabajar más, tengamos otros médicos igualmente dedicados que nos brinden apoyo y continúen con nuestra labor” , añadió.
Además, recordó que en 2017 realizaron el primer trasplante alogénico moderno en un paciente adulto con leucemia. “Desde entonces, gracias a Dios, hemos continuado realizando este tipo de trasplantes, atendiendo a más pacientes, y ya hemos superado la cifra de 100 pacientes en el programa de trasplante en el Hospital Auxilio Mutuo”, agregó.
La motivación para investigar estos temas
El doctor también resaltó las contribuciones que ha realizado en el tratamiento del cáncer y explicó cómo se enfocó en esta área. Comentó que siempre le llamaron la atención los pacientes con cáncer de la sangre o malignidades hematológicas, especialmente aquellos que veía en la unidad de leucemia en el Hospital Municipal de San Juan.
“Una de las cosas que me impactó y me frustró mucho fue darme cuenta de que eran muy pocos los pacientes que cumplían con los requisitos para someterse a un trasplante de médula ósea con un donante. Eran casos que podrían potencialmente beneficiarse de este tipo de trasplante” , recordó.
Fue a raíz de este análisis que se motivó a ayudar a esta población y decidió especializarse en el trasplante de médula ósea, con el objetivo de regresar a su Puerto Rico natal y establecer un programa que ofreciera este tipo de trasplante alogénico. De esta manera, pudo marcar la diferencia para aquellos pacientes con leucemia
15 @BeH ea lt hP R
que antes no tenían la oportunidad de recibir este tipo de trasplante en la isla o de viajar fuera de la isla para obtenerlo.
Aunque expresó su deseo de no abandonar nunca la medicina, el Dr. Cruz Chacón reconoce que todo tiene un final. “Uno no debe vivir para trabajar, sino trabajar para vivir”, reflexionó.
“Si tuviera la oportunidad y tuviera que mencionar una edad para retirarme, diría que entre los 60 y 65 años. Sé que será difícil llegar a ese punto de jubilación, pero si llega el momento, sería la edad en la que reduciría mi ritmo de trabajo y la intensidad con la que lo hago ahora” , reveló.
Además, reafirmó su compromiso con sus pacientes afirmando que “como oncólogo, apuesto por encima de todo a mis pacientes, porque son verdaderos guerreros”.
El doctor reconoció que dedicarse a esta área de la medicina implica grandes sacrificios, y en ocasiones su familia cuestiona su elección. Sin embargo, él continúa avanzando en su labor.

“No ha sido fácil para mi familia, mi esposa, mis hijos. A pesar de eso, ellos son mi apoyo y lo que me da fuerzas y energía para seguir adelante, a pesar de lo frustrante y agotador que puede ser este trabajo” , resaltó.
Los pacientes siguen siendo una fuente de motivación para el doctor, recargando sus baterías. “Siempre logro encontrar un equilibrio y buscar formas de no descuidarlos”, comentó. Además, añadió: “Mi motivación en todo lo que hago es brindar a estos pacientes la oportunidad de buscar una cura para una enfermedad tan trágica, tan devastadora como el cáncer. Busco asegurar que tengan la mejor calidad de vida posible para disfrutar del tiempo que les queda junto a su familia y seres queridos, y lograr sus sueños y metas”, concluyó el Dr. Cruz Chacón.
www.behealthoncologia.com
16



17 @BeH ea lt hP R @SociedadAmericanaContraElCancerDePuertoRico www.cancer.org 787-764-2295 Educación, prevención y detección: los pilares de la Sociedad Americana Contra el Cáncer de Puerto Rico en la lucha contra el cáncer
Por: Redacción BeHealth

En BeHealth seguimos adelante con nuestra campaña de concientización sobre los cánceres sanguíneos y por eso traemos las perspectivas de destacados médicos puertorriqueños que, desde su amplia experiencia en la oncología hematología, traen explicaciones para conocer más del tema.


En el caso de la leucemia, que suele ser una de las patologías más comunes en Puerto Rico, el Dr. Héctor Vélez, hematólogo-oncólogo, explicó que el tejido blando que se encuentra en el centro de los huesos, donde se forman las células sanguíneas, llama mucho la atención de la parte clínica, debido a que es severa y su atención es considerada de emergencia.
“Los tratamientos son intensos, el equipo necesario para tratar a estas personas no está disponible en todas las áreas de Puerto Rico, y entonces urge agilizar el diagnóstico y canalizar al paciente a un cuidado adecuado”, aseguró el galeno.
Los pediátricos
Los más pequeños de la casa, desafortunadamente, también suelen ser víctimas de este tipo de cáncer. Por eso la Dra. Maribel García, hematóloga-oncóloga pediátrica, explicó cuáles son los más comunes en niños: “Los cánceres más comunes en la edad pediátrica (De 0 a 21 años) siguen siendo las leucemias y los linfomas, siendo la leucemia lo más común”, aseveró la oncóloga.
A su vez, afirmó que para 2018 se registraban en promedio 35 casos de leucemia al año y para este año 2022, el registro se ubica en unos 100 casos.
Además, los síndromes mielodisplásicos también suelen ser recurrentes entre la población caribeña y, lamentablemente, son los cánceres de la sangre más agresivos y ocurren cuando las células madre presentes en la médula ósea, encargadas de producir todas las células de la sangre, sufren una transformación debido a una anormalidad genética o una mutación.
“Para evitar la progresión podemos establecer un riesgo basándonos en la anormalidad genética y en las mutaciones que tiene el paciente y manejarlo con el tratamiento”, compartió el destacado doctor Alexis Cruz Chacón, que también es hematólogo - oncólogo.
La ciencia ayuda
Pese a que la mayoría de leucemias son crónicas, el Dr. Vélez aseguró que en buena parte de los casos suelen ser de progresión más lenta gracias a los múltiples avances que se han desarrollado actualmente para mejorar la calidad de vida de estos pacientes.
“Cuando los médicos hablamos de agudo y crónico, nos referimos al tiempo en el que la enfermedad se desarrolla. Lo que es agudo no existía y generalmente se desarrolla en pocos días o semanas y cuando es crónico, es algo que se viene desarro-
www.behealthoncologia.com
18
Qué está pasando con los cánceres sanguíneos en Puerto Rico: expertos opinan
llando con síntomas muy pequeños o sin síntomas y tarda meses e incluso años en comprobarse por laboratorio que el paciente está enfermo o presenta la condición”, explicó el especialista.
Sin embargo, en el caso de los pacientes pediátricos, aún existe mucha desinformación sobre las afecciones que pueden desencadenar. De hecho, la pediatra y oncóloga explicó que, a veces, los signos de la leucemia suelen confundirse con un catarro común o con casos de hemoglobina baja por aspectos como una mala alimentación.
“Es una tragedia, porque lo que puede ser signos de depresión como cansancio, desgano,o todo lo contrario, que el niño esté bien ansioso, la familia piensa que está dentro del contexto y cuando te das cuenta es porque se están complicando y ya tienen las plaquetas bajas y hematomas y moretones de la noche a la mañana donde antes no había nada” lamentó la doctora en diálogo con nuestro equipo periodístico.
No obstante, la doctora García le pidió a los padres y tutores de los niños con cáncer que estén más atentos de lo que puedan vivir sus pequeños para así evitarles que la enfermedad se agravey cause daños mayores. “Lo más importante es que le hagamos caso a lo que el niño siente y que busquemos una revisión profesional”, afirmó.
LAS OPCIONES
Uno de los métodos noveles para el tratamiento de la leucemia y otros tipos de cáncer es el trasplante de médula ósea del que es experto el Dr. Cruz Chacón, quien describió algunos métodos sobre cómo manejarlo.


“El trasplante de médula ósea consiste en reemplazar las células madre defectuosas del paciente con células madre sanas de un donante compatible”, explicó el doctor.
La intención de los tratamientos es evitar que la enfermedad progrese a leucemia aguda, ya que esta última conlleva mayores complicaciones clínicas, aumento de dependencia de transfusiones y un aumento de las células blancas que genera diversas complicaciones.
Pese a que cada día se reportan más factores de riesgo de leucemias y otras condiciones oncológicas como la quimioterapia, la radioterapia, la exposición a químicos y pesticidas, el reconocido doctor dejó una exhortación para ayudar a los pacientes oncológicos de todas las edades.
“Les animo a seguir luchando. Los tratamientos para el síndrome mielodisplásico y la leucemia mielógena aguda han mejorado significativamente. Como oncólogos, contamos con mejores herramientas para tratar estas condiciones, ya sea para curar al paciente o retrasar la progresión de la enfermedad. En Puerto Rico, contamos con opciones de trasplante de médula ósea desde el 2017, y estamos aquí para brindarles apoyo en todo lo que necesiten. Además, estamos trabajando arduamente para ampliar las opciones de tratamientos y estudios clínicos en la isla, para poder llevar a estos pacientes hacia la curación” , concluyó el médico.

19 @BeH ea lt hP R
Dra. Maribel García Hematóloga Oncóloga Pediátrica
Dr. Alexis Cruz Chacón Hematólogo Oncólogo
Dr. Héctor Vélez Hematólogo - Oncólogo
Karina von Gundlach es una joven de veinticinco años llena de sueños que se prepara para culminar su maestría en Music Business en la Universidad de Boston. Hace algunos años fue candidata a Miss Universe Puerto Rico en el reconocido certamen de belleza en representación de su pueblo, Cayey.
De reina de belleza a guerrera contra el cáncer: La historia inspiradora de Karina
Sin embargo, la historia de su vida fue en ese momento, apenas dos semanas antes de que finalizara el concurso, impactada por una realidad que transformó cada una de sus metas y percepciones. Fue en el año 2021 cuando Karina fue diagnosticada con cáncer de mama triple negativo, un tipo de cáncer que afecta mayormente a mujeres de más de cuarenta años.
Su tumor estaba en una etapa avanzada, lo que exigía una acción inmediata. Así que el primer paso en su tratamiento fue discutir el procedimiento y las implicaciones del ataque al tumor con su oncóloga. En su caso, tuvo que someterse a 14 sesiones de quimioterapia, que constituían la primera fase del proceso.
A pesar de que recibió el diagnóstico mientras aún participaba en el concurso de belleza y estaba en proceso de asimilar la noticia, Karina decidió asistir a un ensayo del certamen después de su primera quimioterapia, sin tener conocimiento previo de los efectos secundarios. Se encontró completamente desprevenida en ese momento y al día siguiente comenzó a experimentar los efectos secundarios, como dolores y reacciones corporales. Fue entonces cuando comprendió la gravedad de la situación y la necesidad de tomar medidas.
Karina confesó que la noticia fue abrumadora tanto para ella como para su familia. Era aún muy joven y se encontraba en un momento de la vida lleno de promesas y proyectos ilusionantes.
“En ese momento, mi mente se inundó de preguntas: ¿Por qué a mí? ¿Por qué ahora? Son interrogantes humanas que surgen al recibir una noticia así. Sin embargo, en aquel preciso instante, cuando la oncóloga me comunicaba el diagnóstico, sentí las manos de Dios posadas sobre mis hombros. Dentro de toda la incertidumbre, experimenté una calma y una paz indescriptibles, pues sentí que Dios estaba a mi lado, sosteniéndome, protegiéndome y envolviéndome con su manto de amor y protección. En cada momento escuchaba su voz diciéndome: ‘Estoy contigo. No estás sola. Podrás superar esto y saldrás victoriosa, porque Yo estoy contigo’”, confesó la joven.

Karina tomó la decisión de poner su salud en primer lugar y redactó una carta pública anunciando su retiro del concurso. Mientras se encontraba en el hospital, sosteniendo con una mano el celular y viendo los comentarios, mientras en la otra sostenía el cabellos que se le caía debido a los efectos de la quimioterapia, comprendió que estaba enfrentando una prueba en su vida, un desafío que debía superar.
Durante este proceso, Karina se enfrentó a diversos retos tanto físicos como emocionales. Confesó que no fue fácil aceptar la pérdida de cabello y verse en el espejo sin él. Sin embargo, en medio de la oscuridad, la joven sintió que su fe y su luz interior le permitían comprender que esto no ocurría por casualidad, sino por un propósito mayor que trascendía su propia existencia. Entendió que la fe era fundamental para superar este proceso.
20
www.behealthoncologia.com
Por: Rosmery Cernadas
“Ese fue el momento en el que desperté y me di cuenta de que estaba viviendo esta realidad en carne propia. Después de completar las sesiones de quimioterapia, me sometí a una mastectomía bilateral. Luego, opté por la inmunoterapia como siguiente paso en mi tratamiento”.
Es una realidad que el cáncer no solo afecta físicamente, sino también emocionalmente. Para mantener una actitud positiva y afrontar los desafíos, sus dos pilares fundamentales fueron su familia y sus padres.
“Ellos fueron mis ángeles guardianes durante todo el proceso, brindándome apoyo, fortaleza y cuidados. Desde el momento en que recibí el diagnóstico hasta el momento de la cirugía, estuvieron a mi lado, dándome fuerzas y recordándome que superaría este proceso. Su presencia y amor fueron mi mayor motivación para enfrentar cada día y luchar contra esta enfermedad tan difícil”, contó a BeHealth.
Afortunadamente, Karina hoy se encuentra libre de cáncer. Una noticia-regalo que recibió en las últimas Navidades que le ha permitido seguir persiguiendo sus sueños mientras integra las lecciones que el cáncer le dejó.

“Después de enfrentar el cáncer, mi perspectiva de la vida cambió por completo. Aprendí muchas lecciones en este proceso. Durante mi competencia en un concurso de belleza, pasé de luchar por una corona física a luchar por la corona de mi vida. Descubrí que abrazar nuestra vulnerabilidad es la clave para abrir la puerta hacia la verdadera belleza. La belleza no se define por apariencias superficiales, sino por nuestra esencia y cómo podemos ayudar a los demás. Aprendí que todos tenemos algo especial y único que nos distingue. Lo más importante es la actitud con la que enfrentamos
la adversidad y convertimos nuestra actitud en nuestra armadura de poder en la vida.”
Para Karina compartir su vulnerabilidad respecto al diagnóstico del cáncer ha sido una experiencia hermosa y gratificante y le ha permitido conectar con otras personas que han pasado por situaciones difíciles, incluyendo enfermedades, depresión y ansiedad.
“Si los seres humanos pudiéramos entender que tenemos más cosas en común que diferencias, este mundo sería diferente. A través de mi testimonio, quiero transmitir un mensaje de paz y esperanza a aquellos que lo necesitan, para que encuentren su propósito en la vida y vivan plenamente. La felicidad no se mide por el éxito material, sino por servir a los demás y tener un propósito que nos haga crecer como seres humanos.”
“Antes de terminar, me gustaría enviar un mensaje a todas las chicas jóvenes mayores de 18 años: por favor, cuídense, protéjanse y realícense los estudios de sonomamografía. Aunque seas joven, no estás exenta de tener problemas de salud. Mi mensaje es que se cuiden, porque pueden salvar sus propias vidas”, finalizó Karina en un mensaje para todas las mujeres.
21 @BeH ea lt hP R
Karina von Gundlach Sobreviviente de cáncer de mama
Por: Redacción BeHealth
En BeHealth nos hemos unido a la Dra. Anna Di Marco, una destacada hematóloga-oncóloga, para brindarte una comprensión general sobre los síndromes mielodisplásicos, también conocidos como mielodisplasia. Estos síndromes son una patología oncológica que se origina debido a alteraciones que pueden ocurrir en las células productoras de sangre en la médula ósea, lo cual resulta en la formación de células anormales.


La mielodisplasia y sus implicaciones en la salud: Una visión experta con la Dra. Anna Di Marco
Según la American Cancer Society, estas alteraciones en la médula ósea pueden llevar a una disminución en los recuentos de uno o más tipos de células sanguíneas. La Dra. Di Marco explicó que cuando se presentan estas anomalías, la médula ósea deja de funcionar correctamente y se vuelve “vaga”
“Cuando se produce un defecto en la médula ósea debido a ciertas mutaciones específicas a lo largo de los años, lo denominamos mielodisplasia”, expresó la hematóloga-oncóloga.
Cómo la mielodisplasia afecta al organismo
En la mielodisplasia, las células defectuosas tienden a morir antes que las células normales, y el cuerpo también elimina algunas de las células sanguíneas anormales, lo que resulta en una insuficiencia de células sanguíneas normales. Según la Dra. Di Marco, esta enfermedad puede afectar los glóbulos rojos, los glóbulos blancos y las plaquetas, aunque existen excepciones.
“La mielodisplasia no necesariamente afecta a los tres tipos de células. Si no se reducen los glóbulos blancos,
www.behealthoncologia.com
22
Dra. Ana Di Marco Hematóloga - Oncóloga
que son las defensas, se reducen los glóbulos rojos, que son la hemoglobina, o se reducen las plaquetas, que son importantes para la coagulación. Puede afectar solo una línea, dos o las tres líneas”, agregó la especialista.
Además, la doctora destacó que si un paciente presenta una disminución de glóbulos blancos, puede experimentar infecciones recurrentes, especialmente en pacientes de edad avanzada. Asimismo, la especialista profundizó en cómo este tipo de cáncer afecta a aquellos que padecen la enfermedad.

“Si la mielodisplasia reduce los glóbulos rojos o la hemoglobina en las personas, les causa fatiga, cansancio y lo que se conoce como anemia. Si a las personas se les reducen las plaquetas, tendrán problemas de coagulación, como sangrado nasal, encías sangrantes o moretones frecuentes. Entonces, dependiendo de qué línea esté afectada, experimentaremos diferentes problemas”, precisó.
Aunque esta condición puede causar graves afectaciones a quienes la padecen, la Dra. Di Marco brindó un mensaje tranquilizador a aquellos que reciben este diagnóstico: “Uno puede llevar una vida bastante normal si la disminución de glóbulos blancos, hemoglobina y plaquetas es leve o moderada. Sin embargo, cuando es severa, es necesario tomar medidas y tratar al paciente”.
Por qué se desarrolla la mielodisplasia
Existen varios factores conocidos que contribuyen a la aparición de los síndromes mielodisplásicos (MDS, por sus siglas en inglés). Sin embargo, la edad es uno de los factores más determinantes en el desarrollo de esta condición. La Dra. Di Marco explicó en qué etapa de la vida es más frecuente su aparición.
“La mielodisplasia generalmente surge debido a mutaciones que se han desarrollado en la médula ósea con el tiempo. Por lo general, no es una enfermedad que afecte a personas jóvenes, sino más bien a aquellas de cierta edad. La incidencia es más común a partir de los 70 años”, compartió.
Además, mencionó que aquellos que han estado expuestos a ciertos patógenos tienen una mayor probabilidad de padecer este trastorno oncológico. Asimismo, señaló que “las personas que han recibido quimioterapia en el pasado para tratar linfoma, cáncer de mama, entre otros, están más predispuestas a tener mutaciones en la médula ósea y desarrollar mielodisplasia en el futuro”.
Tratamientos
La Dra. Di Marco destacó que aquellos que padecen algún síndrome mielodisplásico deberán someterse a tratamientos que incluyen el uso de medicamentos, ya sea por vía oral o intravenosa. Aunque se le denomine quimioterapia, aclaró que los pacientes no experimentarán la caída del cabello, una de las preocupaciones más comunes cuando reciben un diagnóstico de mielodisplasia.
23 @BeH ea lt hP R
Por: Rosmery Cernadas
¿Cómo evitar que la mielodisplasia evolucione a leucemia?




























 Dra. Maribel Tirado Hematóloga Oncóloga
Dra. Maribel Tirado Hematóloga Oncóloga
Según estadísticas, un gran porcentaje de pacientes con esta enfermedad desarrolla leucemia. En entrevista con BeHealth, la doctora Maribel Tirado, hematóloga-oncóloga y presidenta de la Facultad Médica del Hospital del Centro Comprensivo de Cáncer de la Universidad de Puerto Rico, afirmó que los síndromes mielodisplásicos se consideran una enfermedad preleucémica. De hecho, 1 de cada 3 pacientes con mielodisplasia desarrollará leucemia aguda en algún momento.
La evolución de la mielodisplasia se caracteriza por tres elementos clave: aumento en el número de blastos (células inmaduras), presencia de citopenias (recuento de células sanguíneas inferior a lo normal) y mutaciones genéticas. Normalmente, un ser humano tiene alrededor del 5% de blastos en la médula ósea, mientras que en pacientes con mielodisplasia este porcentaje puede oscilar entre el 5% y el 20%. Cuando los pacientes superan este umbral de células inmaduras se considera que tienen leucemia.
Para retrasar la progresión de este síndrome a leucemia, especialmente en el grupo de pacientes que requieren numerosas transfusiones, se utilizan medicamentos como la azacitidina y la decitabina, que son agentes desmetilantes. Estos medicamentos ayudan a regular el proceso de maduración de las células sanguíneas y pueden ser beneficiosos en la gestión de la mielodisplasia.
La doctora Tirado explicó que “estos medicamentos desmetilantes tienen la función de activar el ADN de las células para promover una maduración adecuada”. Según estudios citados
www.behealthoncologia.com

24
Los síndromes mielodisplásicos son un conjunto de trastornos que afectan la producción y maduración de las células sanguíneas, lo que puede llevar a síntomas como anemia, aparición de hematomas y aumento en las infecciones.
por Tirado, los pacientes que reciben estos medicamentos tardan hasta diecisiete meses en desarrollar leucemia, mientras que aquellos que no reciben este tipo de tratamiento la desarrollan en un período de diez a once meses. “En esencia, el medicamento provoca un retraso en el desarrollo de la leucemia aguda”, afirmó.
¿Cómo funcionan estos agentes desmetilantes?
En los genes del ser humano existe un grupo de proteínas llamadas metilos, las cuales tienen la función de encapsular el ADN y evitar su expresión. En este caso, los agentes desmetilantes actúan liberando esta restricción y permitiendo que las células puedan llevar a cabo su proceso de maduración.
Como explicó la hematóloga Tirado, “este medicamento no mata las células. Lo que hace es liberarlas para que puedan madurar y cumplir su función”.
Según estudios mencionados por Tirado, aproximadamente el 45% de los pacientes que comienzan a utilizar estos medicamentos logran independizarse de las transfusiones. Sin embargo, aclara que estos agentes desmetilantes no curan la enfermedad, por lo tanto, se recomienda que aquellos pacientes que sean candidatos para un trasplante de médula ósea inicien el proceso de identificación de donantes lo antes posible.
Complicaciones ocasionadas por síndromes mielodisplásicos
Además de la leucemia, los pacientes con síndromes mielodisplásicos pueden enfrentarse a otras complicaciones como:














Sangrado cerebral debido al bajo recuento de plaquetas. Infecciones que pueden derivar en neumonía debido al bajo número de células blancas.


Sobrevida en pacientes con mielodisplasia
Al diagnosticar esta condición se tienen en cuenta varios factores para determinar un pronóstico de vida, entre ellos:
Porcentaje de blastos (células inmaduras) en la sangre
Mutaciones genéticas (citogenética)
Número de citopenias, es decir, bajos niveles de hemoglobina, plaquetas o células blancas















Teniendo en cuenta estas consideraciones se realiza una predicción de la esperanza de vida y la progresión de la enfermedad. Un paciente de bajo riesgo puede tener una sobrevida de ocho a doce meses, mientras que un paciente de alto riesgo puede tener una esperanza de vida de 7 a 8 meses, ya que su condición es mucho más agresiva.

25 @BeH ea lt hP R
Silverio Pérez, reconocido humorista, escritor, orador y músico compositor, ha sido parte de la familia boricua durante más de medio siglo. Si bien muchos lo conocen como un ícono de la radio y la televisión puertorriqueña, pocos conocen de su lucha personal contra el cáncer.

Silverio Pérez: Más allá del humor, una historia de lucha y superación contra el cáncer de próstata
Durante una entrevista con BeHealth, nuestro querido amigo Silverio compartió sus experiencias y lecciones aprendidas al superar el cáncer de próstata. Han pasado ya 17 años desde que esta enfermedad llamó a su puerta, pero todo lo que ha aprendido aún resuena en su vida. Él enfatiza que no se considera simplemente un sobreviviente, ya que todos lo somos de una forma u otra. Según él, es “un sobreviviente de tantas cosas, ¿por qué darle al cáncer ese poder? Es solo una de las circunstancias que he enfrentado en mi vida”.
Silverio también señaló con pesar que todavía existen numerosos tabúes en torno al cáncer de próstata y a los exámenes necesarios para su prevención y diagnóstico oportuno, debido al machismo arraigado en nuestra sociedad.
“Los hombres tienden a evitar hablar de temas relacionados con el área del ombligo hacia abajo”. Confesó que en reiteradas ocasiones le han abordado discretamente para preguntarle acerca de su experiencia con el cáncer de próstata y los
síntomas que experimentó. Eso sí, con mucho disimulo, como si se tratara de algo que debería ocultarse.

“Solía visitar a mi urólogo regularmente, y en un determinado momento, él notó que mis niveles de PSA estaban un poco elevados, aunque aún dentro de los rangos normales. Volvimos a hacer pruebas después de 3 o 4 meses, y los niveles habían aumentado aún más”. Fue entonces cuando decidió realizar una biopsia, y se descubrieron células cancerosas agresivas que aún estaban localizadas dentro de la próstata, lo que indicaba la posibilidad de una cirugía.
Respecto a su reacción, admitió que quedó en estado de shock y no pudo escuchar lo que el médico estaba diciendo en ese momento. Solo pudo sentir la mano sudorosa y fría de Yessica, su esposa.
26
www.behealthoncologia.com
Por: Rosmery Cernadas
Por: Rosmery Cernadas
Silverio Pérez Humorista, escritor, orador y músico compositor
“Internamente, experimenté una tremenda turbulencia emocional, ya que asociamos la palabra ‘cáncer’ con la muerte. En ese momento, sabía que no podía pensar con claridad, así que comencé a respirar y a tratar de conectarme con el presente”.

Una vez calmado, Silverio preguntó a su médico: “¿Qué debo hacer?”. Fue entonces cuando le informaron sobre las opciones de tratamiento disponibles. Decidió optar por la cirugía, a pesar de los mitos que existen sobre los posibles efectos secundarios, como la incontinencia urinaria y la disfunción eréctil. Priorizó su salud y el bienestar de su familia.
Afortunadamente, no necesitó radioterapia y, entre risas, confesó que durante los primeros tiempos después de la cirugía, usó pañales junto con su nieto.
“Es importante que los hombres acudan al urólogo y cuiden de su familia”, es el mensaje principal que Silverio compartió. Además, agregó que el cáncer le permitió crecer en muchos aspectos:
“Comencé a valorarme más en la vida, a hacer ejercicio, a alimentarme mejor y a apreciar las relaciones, que son uno de los regalos más grandes que a menudo subestimamos. Gané mucho a través de mi enfrentamiento con el cáncer, descubrí un mundo desconocido para mí”
Según sus propias palabras, el enfrentamiento con la posibilidad de la muerte lo hizo reflexionar y comprender que tenía una nueva oportunidad, una que debía aprovechar al máximo.
“Para mí es de suma importancia establecer prioridades, como la familia, hacer ejercicio, reservar tiempo para viajar y tener momentos para mí mismo. Pero también es fundamental encontrar tiempo para seguir siendo productivo, ya que
la creación me motiva. Escribir un libro, tomar un curso, dar una charla, realizar este tipo de actividades. A medida que pierdo fuerza en mis músculos, fortalezco mi mente y adquiero sabiduría”.
Actualmente, Silverio encuentra motivación en la lectura, en descubrir nuevas cosas y en aprender a meditar y respirar. “Estas han sido parte de lo que he ganado en este proceso”.
Aunque en un momento determinado pensó “¿por qué a mí?”, inmediatamente descartó ese pensamiento y cambió su diálogo interno. Sabía que necesitaba pasar por esta experiencia para aprender lo que de otra forma no habría aprendido. “Las cosas siempre ocurren por una razón”.
Decidió aprovechar la adversidad como una oportunidad de crecimiento y aprendizaje que de otra manera no habría tenido. Aprendió la importancia de la paciencia, la aceptación y cómo adoptar una mentalidad positiva y creativa ayuda enormemente en la reparación de las células.
Por último, compartió el papel que el humor ha desempeñado en su vida y en su experiencia con el cáncer. Le ha permitido ver la vida desde una perspectiva positiva, llena de amor y paz. Además, ha ayudado a muchas personas a comprender que pueden abordar su propio proceso desde una perspectiva diferente.
27 @BeH ea lt hP R
El cáncer se posiciona como una de las enfermedades con mayor prevalencia en Puerto Rico. Para tratarlo se inauguró en 1962 el primer hospital para pacientes con cáncer: el Hospital Oncológico Dr. Isaac González Martínez.
Por: Paola Vélez Zahira Rodríguez Coordinadora de Servicios de la Liga Puertorriqueña Contra
Hospital Oncológico: Una trayectoria de servicio a pacientes con cáncer en Puerto Rico
Esta institución, creada por el oncólogo González Martínez, sigue funcionando hasta el día de hoy y brinda una atención integral a los pacientes. Tanto la figura del oncólogo como la fundación y desarrollo del hospital han tenido un impacto significativo en la salud pública de Puerto Rico.
Según Zahira Rodríguez, coordinadora de servicios de la Liga Puertorriqueña contra el Cáncer y el hospital, la existencia de esta institución no habría sido posible sin los esfuerzos de González Martínez, quien también se destaca como el primer oncólogo en la isla.
En entrevista con BeHealth, Rodríguez afirmó: “La enfermedad del cáncer comenzó en Puerto Rico a principios del siglo XX, por lo tanto, la figura del Dr. Isaac es de suma importancia, ya que fue el pionero en garantizar los servicios de tratamiento para los pacientes, dado que el
cáncer era una enfermedad totalmente nueva en el mundo en ese entonces”.
Antes del hospital: La Liga Puertorriqueña Contra el Cáncer
La trayectoria del oncólogo González Martínez no solo se limita a la fundación del hospital, sino que también incluye la creación de la Liga Puertorriqueña Contra el Cáncer. Esta organización sin fines de lucro, basada en el voluntariado, ofrece servicios comunitarios para la educación y prevención del cáncer.
Según Rodríguez, la idea de establecer esta Liga surgió durante un viaje del oncólogo a Cuba, donde tuvo la oportunidad de conocer la Liga Contra el Cáncer. Impresionado por su labor, decidió incorporar una entidad similar en Puerto Rico, con el objetivo de beneficiar a los pacientes oncológicos de la isla.

28
www.behealthoncologia.com
el Cáncer y el Hospital Oncológico

29 @BeH ea lt hP R
“Durante su estancia en Cuba, el doctor González Martínez se encontró con la Liga Contra el Cáncer, una organización basada en el voluntariado. Fue allí donde vio la oportunidad de crear un plan educativo y difundir el mensaje de prevención. Tan pronto como llegó a Puerto Rico el 9 de abril de 1938, fundó la Liga Puertorriqueña Contra el Cáncer”, relató Rodríguez.
Para mantener la organización en funcionamiento, González Martínez formó un Comité de Damas que se encargaba de realizar actividades de recaudación de fondos y establecer un grupo educativo.

Según la coordinadora, el trabajo del Comité comenzó en 1938, pero no fue hasta 1942 que lograron inaugurar el primer centro de cáncer en San Juan.
Aunque el sueño del oncólogo era establecer un hospital especializado en cáncer, este deseo y visión se concretaron después de su fallecimiento. Según Rodríguez, el Comité de Damas siguió activo y adquirió un terreno en San Juan para la creación del hospital.
Sin embargo, el municipio de San Juan propuso la creación de la institución en el Centro Médico. Bajo esta solicitud, el 29 de diciembre de 1962 se fundó e inauguró el primer hospital especializado en cáncer en la isla, convirtiéndose en la única institución privada ubicada en el Centro Médico.
“Falleció el doctor Isaac, pero el Comité de Damas continuó con la idea de construir el hospital en el terreno adquirido. Con la colaboración de la alcaldesa de San Juan en ese momento, Doña Felisa Rincón de Gautier, y el secretario de Salud, Guillermo Armona, se ofreció al Comité
30
www.behealthoncologia.com
Cobertura realizada por BeHealth News de la Caminata Da Vida #15, donde el comediante y filántropo Raymond Arrieta, reiteró su compromiso con los pacientes oncológicos en Puerto Rico.
de Damas la oportunidad de establecerlo en el Centro Médico”, mencionó Rodríguez.
Caminata Da Vida transforma el servicio a pacientes oncológicos Durante los últimos 15 años, la Caminata Da Vida, impulsada por el comediante Raymond Arrieta, ha sido el principal proyecto de recaudación de fondos para los pacientes del hospital, logrando recaudar alrededor de 15 millones de dólares en donaciones.

Entre los servicios implementados para los pacientes, Rodríguez destacó el programa de ayuda financiera, dirigido a aquellos que no cuentan con los recursos económicos para cubrir los gastos de su tratamiento.
“Para solicitar esta ayuda, los pacientes pueden acudir a la directora de Trabajo Social, quien les
brindará toda la información necesaria. Se les ofrecen los servicios sin importar su situación económica”, explicó la coordinadora.
Asimismo, destacó que las recaudaciones han permitido al hospital actualizar sus instalaciones y adquirir nueva maquinaria, beneficiando así a los pacientes. “Gracias a estos fondos hemos podido mejorar tanto nuestras instalaciones físicas como nuestras capacidades tecnológicas, equiparándonos con las principales instituciones de Estados Unidos”, expresó la coordinadora.
En cuanto al Centro de Rehabilitación, inaugurado en 2017, se resalta su importancia como la primera institución en Puerto Rico y el Caribe en ofrecer estas instalaciones. Natalia López Cepero, patóloga del habla y gerente del centro, mencionó los servicios disponibles: “En nuestro Centro de Rehabilitación ofrecemos terapia física, ocupacional, del habla y fisiatría para pacientes adultos mayores de 18 años, abarcando diferentes tipos de diagnóstico”.
Además, el hospital ha implementado una iniciativa llamada “Oncológico Sobre Ruedas”, que consiste en una unidad móvil que lleva servicios médicos a diferentes localidades de Puerto Rico. Esta iniciativa, que comenzó en 2015, ofrece pruebas diagnósticas de cáncer y brinda educación a la comunidad puertorriqueña.
31 @BeH ea lt hP R
“Con esta unidad, podemos llegar directamente al paciente para realizar diagnósticos, especialmente considerando que la principal causa de muerte en la isla es el cáncer de seno”, destacó Rodríguez.
El cáncer colorrectal ocupa el tercer lugar en términos de mortalidad por cáncer en los Estados Unidos, con más de 151,000 casos en el país. Ante esta realidad, la comunidad médica ha enfocado sus esfuerzos en desarrollar tratamientos para esta enfermedad.
Por: Paola Vélez
Evalúan opciones de tratamiento quirúrgico para pacientes con cáncer colorrectal
El cáncer colorrectal se posiciona en la tercera causa de muerte por cáncer en los Estados Unidos con un saldo de sobre 151 mil casos en el territorio. Ante este panorama, la ciencia médica ha concentrado sus esfuerzos en desarrollar tratamientos para la condición.
La cirujana colorrectal Marla Torres explicó los distintos tratamientos disponibles para este tipo de cáncer.

“Hay distintos modos de tratar a los pacientes desde cirugía, siempre con intención de curar, versus un tratamiento multidisciplinario donde envuelve la colaboración de los colegas oncólogos, radio oncólogos y cirujanos con el único fin de curar a los pacientes”,indicó Torres para BeHealth. La cirujana expresó que con un diagnóstico temprano de la condición, los pacientes se pueden someter a tratamientos poco invasivos como la colonoscopía. Este procedimiento consta de eliminar el pólipo canceroso de la zona afectada.
Dra. Marla Torres Cirujana Colorrectal
“El cáncer colorrectal en etapa temprana, su tratamiento puede ser tan simple como endoscópico porque un pólipo canceroso se puede eliminar a través de una colonoscopia. Una evaluación patológica nos deja saber si ese tratamiento fue adecuado”, explicó la especialista.



En caso de que el cáncer ya esté avanzado y ocupe las paredes del intestino, Torres recomienda realizar una colectomía. Este procedimiento se destaca por ser una técnica mínimamente invasiva.
“Cuando el cáncer está invadiendo las paredes del intestino, lo correcto es hacer una cirugía o una colectomía, que es la remoción del tumor a través de la eliminación de un pedazo de nuestro intestino”, resaltó la cirujana.
Como otra opción de tratamiento, mencionó la laparoscopia, una cirugía que une las partes del intestino. Esta es beneficiosa para el paciente
32
www.behealthoncologia.com
pues provee al paciente la oportunidad de recuperar la funcionalidad renal.
“Este procedimiento permite que el paciente tenga retorno de función renal más temprano, menos dolor y una estadía más corta en el hospital. También, las cicatrices son muy pequeñas”, explicó Torres sobre el proceso y beneficios de la laparoscopia.
Cáncer colorrectal, ¿cómo lo abordan los especialistas?



Aunque el cáncer colorrectal se entiende como una sola condición, Torres aseguró que los médicos la dividen entre cáncer de colon y recto. Esto debido a que los tratamientos serán
diferentes según la ubicación del cáncer entre los dos órganos.
Cuando el paciente tiene un diagnóstico de cáncer de colon, mayormente el tratamiento incluye cirugía: “el colon ascendente transverso descendente sigmoide, por lo general su tratamiento es quirúrgico y luego de un estadio patológico, sabremos si el paciente necesita tratamiento sistémico”.

Por su parte, resaltó que si el cáncer es rectal, existen diversas modalidades de tratamiento. Para decidir cuál es la adecuada, la especialista evalúa la localización del tumor canceroso y su distancia respecto al año. Como opciones de diagnóstico, mencionó los MRI, sonogramas endoanales y estudios de proctoscopia.
Entre los tratamientos para el cáncer del recto, destacó la terapia preoperatoria.
“Los tumores del recto bajo; cuando se categorizan por un estadio dos, tres o hasta cuatro, vamos a necesitar terapia preoperatoria que se conoce como terapia neoadyuvante que se sería quimioterapia o radiación en un intento de encontrar respuesta patológica del tumor, reducirlo y luego tener una cirugía”, explicó Torres sobre el procedimiento.
Apesar de que los tratamientos han avanzado y son curativos, la especialista resaltó la importancia de realizarse las pruebas diagnósticas con regularidad para obtener un diagnóstico en etapa temprana.
“Lo más importante es la prevención. Para ello, no olvide hacer sus pruebas diagnósticas. A partir de los 45 años, contamos con la experiencia necesaria para saber que nuestros pacientes necesitan un cernimiento de cáncer colorrectal, pólipos y otras condiciones intestinales que pueden conducir a ello”, puntualizó la cirujana colorrectal.

33 @BeH ea lt hP R
En ocasiones, la vida nos presenta desafíos inesperados que ponen a prueba nuestra fortaleza y resiliencia. El cáncer es una de esas batallas que puede afectar a cualquier persona, sin importar su estatus, profesión o historia. Hoy queremos compartir el inspirador testimonio de Dagmar Rivera, una talentosa presentadora, cantante y actriz puertorriqueña, quien ha enfrentado y superado el cáncer en tres ocasiones.
Por: Rosmery Cernadas
La valiente lucha de Dagmar Rivera: Venciendo el cáncer en tres ocasiones
Dagmar Rivera en entrevista exclusiva con Lily García de BeHealth compartió sobre las condiciones que han afectado su vida en las dos últimas décadas, así como un mensaje de esperanza para aquellos que transitan una etapa así en sus vidas.

Durante la entrevista, Dagmar confesó que ha decidido compartir abiertamente sus vivencias para evitar que los demás sientan lástima por ella. Su deseo siempre ha sido que la vean “como alguien que enfrenta los desafíos con positivismo y una gran fe”.

“Enfrentar un diagnóstico de cáncer no es fácil, lo sé porque lo he vivido en tres ocasiones. Conozco bien los sentimientos que surgen tanto en uno mismo como en la familia, amigos y compañeros de trabajo. Es una gran lección”, compartió Dagmar. Para ella fue esencial sentirse querida y apoyada por tantas personas con la certeza de que el
amor sana. Según compartió a BeHealth, todos podemos celebrar en los buenos tiempos, “pero es especialmente reconfortante cuando están ahí para ti en los malos momentos”.
También fue fundamental sentir el amor y apoyo de tanta gente, ya que está convencida de que el amor tiene poder de sanación. Durante la entrevista con BeHealth resaltó la importancia de tener a alguien a tu lado en los momentos difíciles, no solo para celebrar los buenos tiempos. “Es especialmente reconfortante contar con apoyo cuando atravesamos momentos difíciles”, afirmó.
Ella no se considera una víctima, sino una auténtica guerrera. El primer cáncer llegó luego de varias dificultades de salud. Y es que durante una cirugía para extirpar un fibroma uterino de considerable tamaño, el médico descubrió que su hígado estaba lleno de quistes. A pesar de no presentar síntomas específicos, Dagmar notaba
www.behealthoncologia.com
34
Dagmar Rivera Presentadora, cantante y actriz
que su estómago estaba ligeramente abultado, pero no experimentaba molestias significativas. Continuaba trabajando y llevando una vida normal.
Los estudios médicos revelaron que Dagmar vivía con solo una pequeña porción de hígado. Sin embargo, si esa parte se llenaba de quistes, tendría que someterse a un trasplante de hígado. “Tuve que considerar la posibilidad de una operación en la que me quitarían el 80% de mi hígado”, explicó.
Fue durante este proceso de salud que descubrieron algo inusual en su columna vertebral. Había algo comprimiendo su médula espinal, impidiendo que la información se transmitiera correctamente para realizar actividades cotidianas como levantar el pie o moverse hacia la derecha. Dagmar vivía con estas dificultades, sin saber que no eran normales. Tomar la decisión de someterse a una cirugía no fue fácil, sobre todo porque existía la posibilidad de no poder volver a caminar. Sin embargo, por fortuna, superó de la mejor manera este proceso.
Luego de estos desafíos llegó el primer diagnóstico de cáncer. Dagmar confesó que el único síntoma que experimentaba era un carraspeo en la garganta y lo atribuía a que, debido a su trabajo, utilizaba demasiado su voz. Tras una biopsia, Dagmar recibió el diagnóstico de cáncer de laringe en las cuerdas vocales. El impacto fue abrumador en ese momento, como ella misma compartió:
“No quería hacer absolutamente nada. No tenía ganas de hablar con nadie ni de ver a nadie. Mi deseo era simplemente esconderme, alejarme y evitar causarle dolor a los demás. Pasé dos semanas trabajando en mi programa sin decirle nada a nadie”.
Sin embargo, pronto tuvo que comenzar el arduo proceso de quimioterapia y radiación, acompañado de un tubo gástrico que le permitía alimentarse. Durante un año, convivió con este tubo, mientras le realizaban análisis de laboratorio cada dos semanas. Si los resultados eran favorables, podía continuar con su tratamiento.
A pesar de todo, Dagmar siempre mantuvo su fe inquebrantable. Su familia, su hijo y su entonces esposo estuvieron a su lado durante todo el proceso. Con profunda gratitud, confesó: “Mi hijo es el ángel enviado por Dios para cuidarme, para velar por mí”.
Además del primer diagnóstico de cáncer, Dagmar fue diagnosticada con cáncer de pulmón debido a metástasis del tumor inicial. De hecho, en la actualidad vive con un solo pulmón.
Finalmente, Dagmar compartió un mensaje de esperanza que resuena en el corazón de todos aquellos que se enfrentan a circunstancias similares: no importa cuán oscura y desafiante sea la batalla contra el cáncer, siempre hay una luz al final del túnel, una salida hacia la sanación y la renovación:
“Es normal sentir que el mundo se ha derrumbado a tu alrededor; eso es algo que debes permitirte experimentar. Debes luchar y enfrentar esta batalla porque, sí, hay una salida. Es un proceso que llevará tiempo y requerirá una sanación en muchos aspectos de tu vida. Al final, te darás cuenta de que no solo has superado el cáncer, sino que tal vez has sanado una relación con un ser querido o has superado otras heridas o traumas del pasado. Es una sanación total, y te sorprenderás al decir: ‘Me he triplicado’”.
35 @BeH ea lt hP R
“Aunque soy la misma persona de antes, ahora me siento triplicada. Si sueño, sueño tres veces; si creo, creo tres veces. Todo se ha multiplicado. Estoy más presente en mi vida”.
El Dr. Luis Delgado Mateu, hematólogo-oncólogo del Hospital
Oncológico Isaac González Martínez perteneciente a la Liga Puertorriqueña contra el Cáncer conversó con BeHealth sobre el cáncer de cabeza y cuello y dio a conocer las estadísticas que se viven actualmente en la isla.
Por: Redacción BeHealth
Sobre el cáncer de cabeza y cuello en Puerto Rico
¿En qué consiste el cáncer de cabeza y cuello? En los últimos años ha habido un aumento en el número de casos de cáncer de cabeza y cuello, y este aumento no se debe necesariamente a hábitos como el tabaco y el alcoholismo, sino al contagio del virus del papiloma humano (VPH).
Según el Dr. Delgado, en Puerto Rico se diagnostican más de 400 casos de cáncer de cabeza y cuello cada año, lo que lo convierte en uno de los diez tumores malignos más comunes en la isla.

Los hombres se ven afectados en mayor medida debido a los hábitos tóxicos. Sin embargo, las últimas estadísticas son preocupantes en términos de la incidencia de tumores relacionados con la exposición al virus del papiloma humano (VPH).
Anteriormente, el VPH estaba principalmente asociado con el cáncer cervical, pero se ha demostrado que puede causar muchas otras formas de cáncer maligno, como el cáncer anal, el cáncer de pene y los cánceres de cabeza y cuello.
“Es importante que la población sea consciente de esto y entienda que no solo el tabaquismo es suficiente como factor de riesgo, sino que también debemos estar atentos a cualquier llaga, cambios en la voz, dificultad para tragar, molestias o úlceras
Dr. Luis Delgado Mateu Hematólogo-Oncólogo
que no sanan por sí solas. Frente a estos síntomas, es crucial buscar ayuda médica”, resaltó el oncólogo.
Estadísticas en Puerto Rico
El cáncer de cabeza y cuello se encuentra entre los diez tipos de cáncer más frecuentes en la población puertorriqueña, especialmente en los hombres.
Se registran más de 400 casos de este tipo de cáncer, que generalmente afecta la cavidad oral, incluyendo las amígdalas, debido a la infección por el virus del papiloma humano (VPH).
“A pesar de las campañas que hemos llevado a cabo para promover la cesación tabáquica, ahora estamos observando otro aspecto”, puntualizó el oncólogo.
El especialista destacó que existen opciones de tratamiento que pueden conducir a la curación de los pacientes, siempre y cuando busquen ayuda profesional de manera oportuna. Sin embargo, la eficacia del tratamiento dependerá en gran medida de cuán temprano el paciente acuda al especialista.

36 www.behealthoncologia.com
¿Cómo se manifiesta la condición oncológica?
En ocasiones, pueden aparecer lesiones en la base de la lengua, pequeñas úlceras, cambios en el habla, dolor o sangrado. Si bien estos no son signos específicos de cáncer de cabeza y cuello, pueden ser motivo de preocupación y servir como una señal para que busques atención médica y te hagas una evaluación.
Factores de riesgo
Tabaquismo
Consumo de alcohol
Incidencia de personas con tumores asociados al VPH
Tratamientos disponibles en Puerto Rico para este tipo de cáncer
Según el oncólogo, los tratamientos para el cáncer de cabeza y cuello incluyen opciones quirúrgicas, como la realización de una biopsia. Además, puede ser necesario recurrir a la radioterapia, la quimioterapia o una combinación de quimioterapia, radioterapia y cirugía, o incluso quimioterapia y radioterapia, dependiendo del caso. Estos tratamientos tienen como objetivo controlar la enfermedad y mejorar la salud del paciente.

¿Cómo prevenirlo?
Existen dos factores principales que tienen un gran impacto en la aparición de estos tipos de cáncer y que pueden prevenirse. Es fundamental abandonar hábitos como el consumo de alcohol y el tabaquismo, ya que esto contribuye de manera favorable a la prevención. En el caso del virus del papiloma humano (VPH), la vacuna resulta efectiva.
El Dr. Delgado explicó que “la mayoría de las personas expuestas al virus del papiloma humano no desarrollarán malignidades”. Sin embargo, alrededor del 10-15%, no de manera inmediata sino varios años después de la exposición, pueden desarrollar malignidades dependiendo del tipo de práctica de intimidad que hayan tenido y su relación con el virus.
Por último, el especialista hizo un llamado a los padres y cuidadores de jóvenes, tanto niños como niñas, a vacunarlos contra el VPH a partir de los 11 años. Esta vacuna es una de las que salva vidas y ha marcado una diferencia significativa en términos de prevención de malignidades.
37 @BeH ea lt hP R
Por: Paola Vélez
Enfrentar un diagnóstico de cáncer es una tarea difícil sin el apoyo de manos amigas. La Sociedad Americana contra el Cáncer, capítulo de Puerto Rico, se ha convertido en esa mano amiga para los pacientes oncológicos en la isla.
Sociedad Americana contra el Cáncer: 50 años de servicio a pacientes oncológicos
En este año, la organización celebra su 50 aniversario como un ente facilitador de servicios para la población oncológica en Puerto Rico. Sus servicios son completamente gratuitos y están disponibles para pacientes de todas las edades en todo el territorio.
Así lo expresó María Cristy, vicepresidenta de Servicios al Paciente, Control de Cáncer y Política Pública de la Sociedad Americana contra el Cáncer de Puerto Rico en una entrevista exclusiva con BeHealth.
“Somos posiblemente la entidad que más dinero invierte en servicios para pacientes. Destinamos más de 1 millón de dólares a brindar estos servicios. Todos los servicios que proporcionamos son completamente gratuitos. Atendemos a pacientes con cualquier tipo de cáncer y de todas las edades”, destacó la ejecutiva.
Conoce sus servicios e iniciativas
Según Cristy, la organización ofrece una amplia gama de servicios para cubrir la mayoría de las necesidades que puedan surgir en pacientes con cáncer en Puerto Rico. Cuentan con cinco oficinas ubicadas en San Juan, Ponce, Caguas,
María Cristy VP de Servicios al Paciente, Control de Cáncer y Política Pública de la Sociedad Americana Contra el Cáncer de PR

Arecibo y Mayagüez, que brindan servicios incluso a los pacientes en Vieques y Culebra. Además, disponen de un centro de llamadas para orientación y asistencia financiera para el costo de los tratamientos.
“Contamos con un centro de servicio para pacientes con especialistas que atienden llamadas telefónicas. Recibimos alrededor de treinta mil llamadas al año, donde nuestros especialistas brindan orientación, ayuda financiera para el tratamiento y les informamos sobre otros programas de apoyo y servicios que ofrecemos”, mencionó Cristy.
Para aquellos pacientes que tienen dificultades para acceder al transporte a sus centros de tratamiento, la organización ofrece también un programa que
38
www.behealthoncologia.com
proporciona asistencia económica para los gastos de traslado, así como coordinación de transporte con agencias privadas.
“Damos asistencia económica a los pacientes para cubrir los gastos de sus citas médicas. Esto se calcula en función de la distancia entre la residencia del paciente y su centro de tratamiento, lo que ayuda a cubrir los costos de gasolina, estacionamiento, entre otros. Si el paciente no tiene transporte disponible, también ofrecemos servicios de transporte a través de compañías privadas”, explicó la ejecutiva.
Cristy destacó que estos servicios también se extienden a la población pediátrica. Además, la organización celebra el campamento de verano “Sonrisa”, donde cada niño asiste acompañado por un compañero de su edad durante un fin de semana. Este evento se ha llevado a cabo durante aproximadamente quince años y cuenta con la participación anual de entre 80 y 100 niños.
“Durante el campamento, los niños tienen la oportunidad de compartir con un equipo gigante de voluntarios y especialistas, como médicos, emergenciólogos y enfermeras. Es una excelente oportunidad para que los niños establezcan contacto con otros niños que están pasando por experiencias similares”, mencionó Cristy.
Además, la sociedad cuenta con un programa de becas estudiantiles que beneficia tanto a jóvenes pacientes como a sobrevivientes de cáncer:
trasladarse de una escuela pública

39 @BeH ea lt hP R
“Hace 20 años pusimos en marcha un Programa de Becas Estudiantiles para jóvenes que se gradúan de la escuela secundaria y desean ingresar a la universidad. También tenemos una beca preuniversitaria para aquellos jóvenes que desean
a una privada”, explicó la ejecutiva sobre el programa.
Directorio de Organizaciones
Para

pacientes con cáncer y sus familiares

FUNDACIÓN CAP
Servicios:
Almuerzo y cena gratuitos para acompañantes de pacientes en la Unidad de Oncología Pediátrica.
Servicios de psicología para niños con cáncer. Terapia física.
Contacto: 787-782-9760
Sitio web: www.fundacioncap.org

FUNDACIÓN ONCOLÓGICA HIMA SAN PABLO
Servicios:
Ayuda económica para estudios, tratamientos y deducibles.
Contacto: 787-664-1775
Sitio web: www.fundaciononcologica.org

FUNDACIÓN DE NIÑOS DE PUERTO RICO
Servicios:
Ayuda económica para costear tratamientos. Laboratorios.
Suministro de medicamentos. Apoyo psicológico. Docentes para continuación de estudios.
Contacto: (787) 622-2200
Sitio web: www.fundaciondeninospr.org

FUNDACIÓN INFANTIL RONALD MCDONALD


Servicios:
Alojamiento para familias fuera del área metropolitana y necesiten tratamiento. Transporte.
Instalaciones de lavandería para las familias alojadas.
Contacto: 787-742-8287 / 787-748-8295
Sitio web: www.casaronald.org.pr
FUNDACIÓN RAYITO DE ESPERANZA
Atención a pacientes pediátricos de 0 a 21 años
Servicios:
Transporte
Ayuda con deducibles de medicamentos y tratamientos
Becas estudiantiles
Meriendas nutritivas
Programa de entretenimiento “Dibujando Esperanza”
Contacto: 787-653-9864 / 787-665-6660
787-665-6672
Sitio web: www.rayitodeesperanzapr.org
41 @BeH ea lt hP R
SOCIEDAD AMERICANA CONTRA EL CÁNCER
Servicios:
Suministro de medicamentos. Transporte.
Estudios médicos. Hospedaje. Grupos de apoyo.
Contacto: 787-764-2295
Sitio web: www.cancerpuertorico.org


SUSAN G. KOMEN PUERTO RICO

Servicios:
Ayuda con deducible de tratamiento. Asistencia con pago de utilidades. Asistencia económica para cubrir gastos de efectos secundarios (ej. bufandas, pelucas, sostenes, etc.)
Contacto: 787-751-9096 / 787-282-6611
Sitio web: www.komenpr.org
LEUKEMIA AND LYMPHOMA SOCIETY

Servicios:
Apoyo económico. Consultas nutricionales. Co-Pagos en tratamientos.
Contacto: 855-314-6950
Sitio web: www.lls.org

LIGA PUERTORRIQUEÑA CONTRA EL CÁNCER
Servicios:
Ayuda financiera
Asistencia para PET Scan. Asistencia para tratamiento y detección.
Contacto: 787-763-4149
Sitio web: www.ligacancerpr.org
FUNDACIÓN MIRTA ENID
Servicios:
Entrega de medicamentos a domicilio.
Transporte a citas médicas. Grupos de apoyo. Orientación nutricional. Charlas educativas sobre prevención.
Contacto:787-400-9006
Sitio web: https://fundacionmirtaenid.org/contact/
42
www.behealthoncologia.com
Gracias a una persona que creyó en la donación, Chris Montes, recibió un trasplante de hígado cuando era adolescente. Hoy vive agradecido con su donante, logrando cumplir sus sueños. REGÍSTRATE COMO DONANTE DE ÓRGANOS Y TEJIDOS EN: DONEVIDAPUERTORICO.ORG


 Por: Redacción BeHealth
Por: Redacción BeHealth
El Dr. Pedro Solivan hematólogo-oncólogo, acompañó a BeHealth es su programación especial bajo la iniciativa ‘Edúcate Sobre el Cáncer de Pulmón’, con el fin de concienciar y educar sobre esta condición. Según el especialista, el cáncer de pulmón podría representar el 10% de todos los casos diagnosticados anualmente en la isla. Además, agregó que se han registrado entre 70 y 80 casos al año en todas las zonas de Puerto Rico, según los datos recopilados por los oncólogos.
Dr. Pedro Solivan Hematólogo - Oncólogo




Manejo del cáncer de pulmón en Puerto Rico: ¿cuál es la situación actual?
¿Afecta en mayor medida a hombres o mujeres?
Aunque es más común en hombres, la prevalencia del cáncer de pulmón puede estar relacionada con diferentes factores de riesgo, por lo que es necesario considerar múltiples variables para determinar su incidencia en ambos géneros.
Edad de mayor detección
Según el Dr. Solivan, este tipo de cáncer suele diagnosticarse con mayor frecuencia entre los 60 y 65 años, aunque puede presentarse en cualquier etapa de la vida.
“Es impresionante, pero también estamos diagnosticando pacientes de 90 años con cáncer de pulmón”, resaltó el oncólogo.
¿Qué tipo de cáncer de pulmón se diagnostica en personas que nunca han fumado?
En estos casos, el especialista señala que podría tratarse de un cáncer de pulmón de origen genético, no inducido por factores de riesgo relacionados con el tabaco. Este tipo de cáncer
se caracteriza por tener mutaciones específicas que pueden ser tratadas con terapias dirigidas.
¿Cómo se encuentra Puerto Rico en términos de tratamientos?
Aunque Puerto Rico cuenta con opciones de tratamiento comparables a las de Estados Unidos, existen disparidades en el diagnóstico, ya que no se disponen de todas las facilidades necesarias, especialmente para personas con recursos económicos limitados.
“Aunque Puerto Rico no se encuentra en una situación de pobreza, como país enfrentamos dificultades en términos de población y una economía en crecimiento con bajos ingresos”, destacó.
El especialista enfatizó en la importancia de un trato equitativo y una atención oportuna, subrayó que no encuentra justificación para que los pacientes enfrenten dificultades en la cobertura de sus necesidades médicas. Por tanto, hizo un llamado a buscar ayuda para recibir diagnóstico y tratamiento a tiempo.
44 www.behealthoncologia.com

¡Con amor y esperanza te ayudamos a sobrellevar esta enfermedad! @fundacionmirtaenid @mirtaenid www.fundacionmirtaenid.org 787-400-9006 ¡JUNTOS VENCEREMOS EL CÁNCER DE PULMÓN!
Bajo la misión de brindar asistencia y facilitar el proceso de tratamiento a los pacientes con cáncer de pulmón en Puerto Rico, la Fundación Mirta Enid ha estado proporcionando servicios de ayuda desde su inauguración en 2016.
Por: Paola Vélez
Fundación Mirta Enid: Un enlace de ayuda a pacientes con cáncer de pulmón
Así lo afirmó Luis Osvaldo Rodríguez Colón, fundador de la organización, en entrevista exclusiva con BeHealth. “Desde que establecimos la fundación en 2016 hemos experimentado un increíble crecimiento y brindado una gran ayuda a los pacientes que lo necesitan”.

El fundador reconoce la necesidad económica que enfrentan muchos pacientes que no cuentan con los recursos para cubrir los gastos de los tratamientos médicos contra el cáncer. Esta preocupación no es ajena para Rodríguez Colón, ya que él mismo la vivió junto a su hija, quien falleció a causa de un cáncer de pulmón.
Rodríguez Colón compartió su experiencia personal: “Con nuestra hija encontramos que los costos de los tratamientos son extremadamente altos, y a menudo el problema radica en que las
Luis Osvaldo
aseguradoras solo cubren ciertos exámenes una vez al año, lo cual puede resultar demasiado tarde en algunas ocasiones”.
Para brindar apoyo a los pacientes, la fundación cuenta con un programa de apoyo financiero. “En ese aspecto, estamos aquí para ofrecer una ayuda que, aunque no sea completa, permite al paciente acceder al tratamiento que necesita con urgencia. También proporcionamos asistencia para medicamentos que no estén cubiertos y para pruebas de laboratorio”, explicó el fundador de la organización.
La fundación brinda asistencia financiera a las instituciones donde los pacientes reciben tratamiento, sin importar su diagnóstico de cáncer. Para determinar el nivel de ayuda que se proporcionará, se evalúan los ingresos económicos del paciente y su familia.



46
www.behealthoncologia.com
Rodríguez Colón Fundador de la Fundación Mirta Enid
“Es importante destacar que la ayuda monetaria no se otorga directamente al paciente en efectivo, sino que se destina a la farmacia, el laboratorio o el hospital. Calculamos los porcentajes de ayuda en función de los ingresos económicos del paciente y su familia”, explicó el ejecutivo en referencia al programa.
Educación y prevención para el paciente y sus familiares
Entre las misiones de la organización, Rodríguez Colón destaca la importancia de promover la educación, la prevención y la detección temprana del cáncer en la comunidad puertorriqueña. La entidad también ofrece talleres educativos tanto para los pacientes como para sus familiares.
“Una de nuestras misiones es la prevención del cáncer y la promoción de la salud en general. Regularmente llevamos a cabo charlas y talleres cada dos meses para educar a la población adulta y joven sobre el cáncer y las medidas de prevención que deben tomarse”, mencionó el fundador de la organización.
Además, señaló que los talleres también están abiertos a los cuidadores de los pacientes: “para que puedan aprender cómo ayudar mejor al paciente y conocer los recursos y lugares donde pueden obtener orientación” .
Rodríguez Colón reconoce que el proceso de enfrentar un diagnóstico de cáncer es difícil y doloroso. El fundador recomendó a los pacientes buscar apoyo espiritual y de las diversas organizaciones en Puerto Rico que pueden brindarles asistencia.
La Fundación Mirta Enid es una organización sin fines de lucro dedicada a los pacientes con cáncer de pulmón, sus familiares y cuidadores. Para recibir más información o convertirse en miembro, ingrese a su sitio web.























47 @BeH ea lt hP R
Ciertos tipos de VPH, denominados de «alto riesgo», aumentan la probabilidad de desarrollar determinados tipos de cáncer como el de ano, cáncer de cuello uterino, cáncer de pene, cáncer de mama, cáncer de vulva, cáncer de vagina y cáncer de cabeza y cuello.
Conoce los tipos de cánceres relacionados al VPH y cómo prevenirlos
Algunos tipos de VPH, denominados de “alto riesgo”, aumentan la probabilidad de desarrollar cánceres específicos, como el cáncer de ano, el cáncer de cuello uterino, el cáncer de pene, el cáncer de mama, el cáncer de vulva, el cáncer de vagina y el cáncer de cabeza y cuello. Estimaciones recientes indican que más del 5% de todos los cánceres pueden atribuirse al VPH.
El cáncer, dentro de los múltiples y raros tipos existentes, también podría presentarse en la boca y varios de sus componentes. En BeHealth contactamos a la Dra. Elba Díaz, odontóloga certificada en oncología oral para ampliar la información.

“Se denominan cánceres de cabeza y cuello aquellos que se encuentran en la cavidad oral. Sin embargo, dentro de la cavidad oral, también se subclasifican según las diferentes áreas anatómicas. Por ejemplo, si el cáncer se localiza en la lengua, se denomina cáncer de lengua; si afecta el paladar, se trata de un cáncer de paladar, y así sucesivamente. Por lo tanto, el cáncer oral se encuentra en la parte
frontal de la boca, y a medida que avanzamos hacia la parte posterior después de las amígdalas y la úvula, nos adentramos en lo que se conoce como orofaringe, que es el área que conecta la parte oral con la faringe”, explicó la Dra. Elba Díaz.
Recurrencia de este tipo de cáncer
Según el Instituto Nacional de Salud (NIH), el cáncer oral representa aproximadamente el tres por ciento de todos los casos de cáncer diagnosticados anualmente en los Estados Unidos. Esto equivale a cerca de 53,000 nuevos casos cada año.
Ahora bien, ¿cuál es la situación en Puerto Rico? La Dra. Díaz resaltó que, en la clasificación epidemiológica del registro de cáncer de Puerto Rico, se incluyen los cánceres orales y los de faringe en la categoría de orofaringe. Además, mencionó que esta enfermedad se encuentra entre las 10 más comunes en términos oncológicos.
“
A nivel mundial, el cáncer oral siempre se encuentra entre los diez cánceres más frecuentes, espe-
48 www.behealthoncologia.com
Por: Redacción BeHealth
Dra. Elba Díaz Odontóloga certificada en Oncología Oral
cialmente en hombres. Lo mismo ocurre en Puerto Rico, donde actualmente es el cáncer con mayor incidencia en detección. En el hemisferio occidental ocupamos el primer lugar, y en el Caribe también somos el país con la incidencia más alta en hombres, siendo el sexto tipo de cáncer más común”, advirtió la odontóloga.
Factores de riesgo
La mayoría de los casos de cáncer oral están relacionados con el consumo de tabaco, el consumo de bebidas alcohólicas o la infección con el virus del papiloma humano (VPH), e incluso puede haber una combinación de estos factores.
“La etiología de estos cánceres es muy similar a la de los cánceres de orofaringe, generalmente afectan la mucosa o las áreas anatómicas mencionadas. Sin embargo, cuando hablamos de cáncer de cuello o cáncer de cerebro, la etiología es diferente y se trata de otro tipo de cáncer. Pero en el caso de los cánceres de orofaringe y otras áreas mencionadas, se aborda de manera similar”, agregó la Dra. Díaz.
VPH y su relación con los cánceres de cabeza y cuello
El cáncer de orofaringe es un tipo de cáncer de cabeza y cuello que está directamente asociado al virus del papiloma humano (VPH). Sin embargo, otros tipos de cáncer de cabeza y cuello, como el de cavidad oral y laringe, no tienen una relación directa con la infección por VPH.
El VPH puede causar tumores en la parte posterior de la garganta, en la base de la lengua y en las amígdalas, formando un área conocida como orofaringe. Estos tumores se denominan tumores orofaríngeos y forman parte del grupo de cánceres de cabeza y cuello.
Se estima que alrededor de 45,000 nuevos casos de cáncer de cabeza y cuello en todo el mundo pueden atribuirse a la infección por VPH cada año.
Este vínculo, que se estableció hace casi 20 años, ha llevado recientemente a ampliar la vacunación contra el virus también a los hombres. Esto se debe a que el virus del papiloma, contrario a lo que se podría pensar, es un agente cancerígeno en los tumores de la cavidad oral, la faringe y la laringe, al igual que el alcohol y el tabaco.
¿Qué tan comunes son los cánceres de cabeza y cuello relacionados con el VPH?
La incidencia de cánceres de cabeza y cuello relacionados con el VPH está experimentando un rápido aumento a nivel mundial. Es importante destacar que los pacientes con cáncer de cabeza y cuello asociado al VPH suelen ser más jóvenes, tener una buena salud y es posible que no tengan antecedentes habituales de consumo excesivo de tabaco o alcohol.
IMPORTANCIA DE LA VACUNA
A la luz de estos importantes hallazgos, la vacunación se vuelve más crucial que nunca y se recomienda tanto para mujeres como para hombres. La aplicación de la vacuna no solo es importante para prevenir el desarrollo de la enfermedad, sino también para acelerar el control de la propagación del virus. Los hombres no inmunizados siguen siendo portadores y pueden transmitir el virus a las mujeres.
Las recomendaciones actuales de vacunación contra el virus del papiloma humano incluyen a niñas y niños entre los 11 y 12 años, y se sugiere completar las dosis antes de los 13 años. Además, se recomienda que los jóvenes y adultos jóvenes no vacunados se vacunen hasta los 21 años en el caso de los hombres y hasta los 26 años en el caso de las mujeres.
49 @BeH ea lt hP R
Por: Redacción BeHealth
El Dr. Cristian Rodríguez, hematólogo-oncólogo, fue invitado al programa especial “Mieloma múltiple, la vida después de un trasplante” organizado por BeHealth. Durante su participación, el Dr. Rodríguez destacó los síntomas de alerta que pueden indicar la presencia de esta condición, así como los cambios en el estilo de vida que se sugieren para mejorar la calidad de vida de los pacientes.
 Cristian Rodríguez Hematólogo-Oncólogo
Cristian Rodríguez Hematólogo-Oncólogo


¿Qué es mieloma múltiple?
El mieloma múltiple es una enfermedad del sistema inmunológico que afecta a las células plasmáticas, las cuales son responsables de producir anticuerpos. Estos anticuerpos son proteínas secretadas por el sistema inmunológico en respuesta a sustancias extrañas como virus, bacterias, parásitos o células cancerosas.
“El mieloma múltiple es un crecimiento descontrolado de las células plasmáticas que lleva a la secreción anormal de proteínas que se acumulan en distintos órganos y crean daño a órganos”, explicó el especialista.
Cuando las células plasmáticas comienzan a crecer de manera descontrolada, se produce un exceso de secreción de proteínas y se desarrolla el mieloma múltiple. Esta sobreproducción de proteínas anormales puede acumularse en diferentes órganos, causando daño a los mismos.
El mieloma múltiple puede afectar los huesos, los riñones y manifestarse a través de episodios de anemia y otros síntomas clínicos.
Síntomas del mieloma múltiple
Los signos y síntomas del mieloma múltiple pueden variar y, en la etapa inicial de la enfermedad, puede no haber ninguno.
Cuando se manifiestan los signos y síntomas, estos pueden comprender:
Dolor en los huesos, especialmente en la columna vertebral o en el pecho
Náuseas
Estreñimiento

Pérdida de apetito
Desorientación o confusión mental
Fatiga
Infecciones frecuentes
Adelgazamiento
Debilidad o entumecimiento en las piernas
Sed excesiva
www.behealthoncologia.com
50
Mieloma múltiple: signos de alerta y alternativas para mejorar la condición
Dr.
Diagnóstico de mieloma múltiple

El diagnóstico del mieloma múltiple a menudo se realiza de forma accidental durante exámenes de laboratorio de rutina. También puede detectarse a través de pruebas que revelan niveles elevados de proteínas en el análisis químico, así como a través de fracturas patológicas.
El especialista destacó que cuando ocurre una fractura después de una caída desde una altura como la de una silla, esto nos indica clínicamente que algo no está normal. Este tipo de manifestación física puede ser una señal de alerta para el diagnóstico de mieloma múltiple.
crecimiento descontrolado de las células plasmáticas que lleva a la secreción anormal de proteínas que se acumulan en distintos órganos y crean daño a órganos”.
Tratamientos para el mieloma múltiple
En la actualidad se suele recomendar la triple terapia para el tratamiento del mieloma múltiple, siempre y cuando sea posible. Sin embargo, es importante evaluar cada caso individualmente, especialmente en pacientes frágiles o de edad avanzada, como aquellos en sus 80 años, quienes pueden presentar efectos adversos a estas terapias. En estos casos, se puede considerar el uso de dos drogas en lugar de tres.
El especialista destacó que, en general, “se recomienda el uso de tres drogas debido a que se ha demostrado que mejora la supervivencia en los
51 @BeH ea lt hP R
“El mieloma múltiple es un
pacientes con mieloma múltiple”. Sin embargo, la decisión final sobre el tipo de terapia a seguir debe basarse en la evaluación exhaustiva de cada paciente y tener en cuenta su estado de salud y otros factores individuales.
Mieloma, una condición clasificada por riesgos La enfermedad del mieloma múltiple se clasifica según los cambios genéticos, ya que en algunos casos puede haber recurrencia de la enfermedad.
Debido a esta complejidad, el tratamiento del mieloma múltiple se basa en la administración simultánea de tres drogas. El objetivo es lograr una remisión profunda de la enfermedad desde el primer tratamiento.
El doctor precisó que la respuesta al primer tratamiento es crucial para la supervivencia a largo plazo. Cuanto más profunda sea la respuesta obtenida en el primer tratamiento, mejores serán las perspectivas de supervivencia.
El Dr. Rodríguez también advirtió sobre los daños que pueden ocasionar las células plasmáticas “que crecen descontroladamente y producen anticuerpos o proteínas en exceso, lo cual puede afectar a diferentes órganos”.
¿Qué tipos de daños se pueden presentar?
Aumento del calcio en sangre.
Alteraciones radiológicas o analíticas, que pueden reflejarse en los resultados de pruebas de laboratorio o estudios de imagen.
Anemia, que se caracteriza por una disminución en los niveles de glóbulos rojos y puede causar fatiga y debilidad.
Fallo renal, cuando los riñones no funcionan correctamente debido al daño causado. Fracturas de huesos, que pueden ocurrir debido a la debilitación ósea.
Estas complicaciones pueden variar en su gravedad y requerirán atención médica y tratamiento adecuados para abordarlas de manera efectiva. Cuando la proteína es detectada con daño a órganos es lo que se conoce como mieloma múltiple.

Cambios en el estilo de vida para mejorar la condición
Para mejorar la condición del paciente con mieloma múltiple se recomienda realizar cambios en el estilo de vida, siempre y cuando el paciente no sea frágil o presente fracturas. Se sugiere seguir un ritmo de actividad física adecuado según lo permita el cuerpo.
El especialista destacó que es importante fomentar el uso de medicamentos para mantener la salud ósea como parte del cuidado integral del paciente.
En Puerto Rico se cuenta con profesionales capacitados para tratar al paciente desde las etapas iniciales de la enfermedad y se ofrecen alternativas de tratamiento que buscan mejorar su calidad de vida.
52
www.behealthoncologia.com
Un estudio realizado por médicos italianos, detectó que la transmisión orogenital del VPH se posicionó como el factor principal de riesgo para los cánceres orales.
La investigación determinó que: El VPH supera al tabaquismo yal alcoholismo como elementos
Riesgo Bajo
Presencia de verrugas en los genitales, ano, garganta o boca
Riesgo Alto




Puede generar cáncer del cuello uterino, cáncer anal, cancer vaginal, cáncer del pene o cáncer de boca y garganta.

Se recomienda la prevención primaria contra el virus mediante la vacunación.

53 @BeH ea lt hP R
VPH VIRUS DEL PAPILOMA
Por: Rosmery Cernadas
La piel es el órgano más grande del cuerpo humano y cumple un papel vital en nuestra salud y bienestar. Sin embargo, a menudo subestimamos la importancia de cuidarla adecuadamente. En particular, el cuidado de la piel adquiere una relevancia aún mayor cuando se trata de prevenir el cáncer de piel, una enfermedad que afecta a millones de personas en todo el mundo.
Cuidado de la piel: Tu mejor defensa contra el cáncer de piel
El cáncer de piel es el tipo de cáncer más común, pero también es uno de los más prevenibles. La exposición excesiva a la radiación ultravioleta (UV), ya sea del sol o de fuentes artificiales como las camas de bronceado, es el principal factor de riesgo para desarrollar esta enfermedad.
Para hablar sobre este tema, BeHealth realizó una entrevista exclusiva con el Dr. Fitzgeraldo Sánchez, reconocido dermatólogo de Puerto Rico. El especialista precisó que, si bien tomar el sol es beneficioso, debido a la obtención de vitamina D, hay que tener claridad de que existen diferentes tipos de cáncer de piel.

¿Cómo se manifiesta el melanoma?
En su mayoría, el melanoma se manifiesta a través de un lunar que cambia con el tiempo. Puede ser un lunar existente que se modifica o puede aparecer uno nuevo “Por ejemplo, podrías notar un lunar en tu hombro que era de color marrón y que lleva seis meses cambiando a un tono marrón amarillento, con bordes irregulares y que no sana adecuadamente. También podría presentar sangrado ocasional. Estos cambios
Dr. Fitzgeraldo Sánchez Dermatólogo



54 www.behealthoncologia.com
“El cáncer más común es el carcinoma basocelular, seguido por el carcinoma escamoso, pero hoy nos centraremos en el melanoma maligno, el más peligroso de todos”, especificó.
son indicadores de una posible evolución maligna”, compartió el doctor Sánchez.
¿Cómo se diagnostica el melanoma?

Para el diagnóstico, lo más común es realizar una biopsia, donde se toma una parte del lunar para su posterior análisis por un patólogo. Así, en función de la profundidad y la clasificación del melanoma, se determina el siguiente paso a seguir.
Si el melanoma es más superficial, se puede realizar una extirpación quirúrgica localizada. En casos más profundos, como los de estadio tres o cuatro, se requiere un enfoque más agresivo, incluso con la posibilidad de realizar biopsias de los ganglios linfáticos cercanos para verificar si el melanoma se ha diseminado a otras áreas del cuerpo. Esto nos
indica que el melanoma puede convertirse en algo mucho más grave si no se trata a tiempo.
“La prevención y la detección temprana son fundamentales en cualquier enfermedad, incluido el melanoma. Es importante revisar nuestros lunares, examinar nuestro cuerpo y buscar signos de evolución utilizando el método ABCDE: asimetría, bordes irregulares, colores cambiantes, diámetro superior a 6 mm y evolución”, compartió el dermatólogo.
Asimismo, si se observa alguna de estas características es recomendable acudir al dermatólogo para un chequeo temprano. Cuanto antes se detecte, menor será la intervención necesaria y menos grave será la situación.
¿Podemos prevenir el melanoma?
La prevención también juega un papel crucial, especialmente en lugares donde el sol es intenso, como en Puerto Rico. Según recomendó el galeno, es esencial tratar de realizar actividades al aire libre temprano en la mañana o después de las tres o cuatro de la tarde, cuando el sol no es tan intenso. Además, es importante utilizar ropa protectora, gafas de sol y aplicar protector solar cada hora o dos horas. Si esto resulta complicado, la ropa protectora puede ser una buena alternativa, ya que brinda una cobertura menos laboriosa.
“La autoexploración también es clave. Debes revisarte la piel regularmente para detectar posibles cambios en los lunares y acudir al dermatólogo al menos cada seis meses o cada año para un examen de piel profesional”, agregó también el especialista. En cuanto a los protectores solares, el doctor explicó que la diferencia entre un factor de protección solar (FPS) de 30 y 50 es mínima en términos de protección. Después de FPS 30, la diferencia se reduce a cuestión de minutos. Se recomienda reaplicar el protector solar cada una o dos horas, especialmente si hay exposición prolongada al
55 @BeH ea lt hP R
sol o sudoración intensa. En condiciones de alta humedad o actividad física intensa, como caminar bajo el sol o estar en la playa, se puede considerar reaplicar cada hora. El uso de ropa protectora también es altamente recomendado.
Estadísticas de melanoma en Puerto Rico
En cuanto a la incidencia de melanoma en Puerto Rico, es similar a la de Estados Unidos debido a la diversidad de tipos de piel presentes en la población.
“Aquí abarcamos todo el espectro de tipos de piel, desde el tipo 1 (piel más clara y propensa a quemarse) hasta el tipo 5 y 6 (piel más oscura y resistente a quemarse)”. Adicionalmente, en la isla aproximadamente un 2.2% de la población total podría desarrollar melanoma, “una de las formas más agresivas de cáncer de piel”.
Otros cánceres de piel a tener en cuenta
Además del melanoma, existen otros tipos de cáncer de piel y el más común de todos es el carcinoma basocelular. A diferencia del melanoma, tiende a no metastatizarse, aunque en raras ocasiones puede hacerlo. Luego está el carcinoma escamoso, que se encuentra en un nivel intermedio. “Estos son los tres tipos más comunes: melanoma maligno, carcinoma basocelular y carcinoma escamoso”
El carcinoma basocelular se distingue del melanoma en su apariencia. Puede tener colores similares a un melanoma y parecer un lunar, pero típicamen-
te se presenta como una pequeña protuberancia en la piel, como una bolita de grasa. Suele encontrarse en áreas expuestas al sol, como la cara, el cuello, las manos y las piernas.
Según el doctor, respecto a las razas y el cáncer de piel, es un error creer que las personas de raza negra no pueden desarrollar cáncer de piel. Lo que ocurre es que las personas con tonos de piel más oscuros tienden a chequear su piel con menos frecuencia. “Si desarrollan un melanoma, puede ser menos visible y, por lo tanto, pasarse por alto”, resaltó.
Es importante que las personas de tonos de piel más oscuros también acudan a su dermatólogo y se hagan chequeos regulares de la piel. De hecho, se ha encontrado que en personas con tonos de piel más oscuros, los melanomas suelen diagnosticarse en etapas más avanzadas debido a la tendencia a ignorar los signos durante más tiempo.
“En términos dermatológicos, las consecuencias de un melanoma maligno no tratado pueden ser graves. Si no se trata, el melanoma puede metastatizar”.
Por ende, la detección temprana y la vigilancia regular de los lunares son fundamentales para evitar estas complicaciones. Se recomienda autoexaminarse la piel utilizando el método ABCDE una vez al mes, y acudir al dermatólogo cada seis o doce meses. Adicionalmente, aquellos que han sufrido quemaduras solares severas, como
56 www.behealthoncologia.com
“En cuanto al carcinoma escamoso, también está relacionado principalmente con la exposición al sol, aunque también puede afectar a pacientes inmunocomprometidos. Se encuentra comúnmente en áreas expuestas al sol, como la cara, el cuello, los hombros, las manos, los brazos y las piernas”, refirió el entrevistado.
quemaduras con ampollas o insolación, deben visitar a su dermatólogo con mayor frecuencia. Realizar estas revisiones periódicas puede ayudar a evitar problemas futuros y detectar cualquier cambio sospechoso a tiempo.
Importancia de las campañas de concientización Además, el doctor señaló la importancia de las campañas de concientización sobre el melanoma, las cuales tienen un efecto significativo en la población. La colaboración de diversas organizaciones en la difusión de información sobre la prevención, detección temprana y protección solar ha contribuido a aumentar la conciencia sobre el tema y fomentar conductas saludables para evitar el melanoma y otros tipos de cáncer de piel.

“Es importante crear conciencia sobre el melanoma y otros tipos de cáncer de piel. A veces, desafortunadamente, la atención pública se centra más en casos famosos. Sin embargo, la mayoría de las personas afectadas por el melanoma
son personas comunes, como nuestras madres, abuelas, tías, amigos y vecinos. Necesitamos generar conciencia en todos los niveles de la sociedad”.
Para finalizar, comentó el doctor que la Sociedad Dermatológica de Puerto Rico está comprometida con la educación y se han unido esfuerzos para traer más dermatólogos a Puerto Rico, donde hay una gran necesidad de especialistas en esta área. En la Escuela de Medicina Ponce se ha acreditado un programa de Dermatología por parte del American College para entrenar a nuevos dermatólogos.
También se están haciendo esfuerzos para retener a estos profesionales en la isla, colaborando con el gobierno de Puerto Rico, el Departamento de Salud, Medicare y el gobierno federal para obtener fondos y promover leyes que incentiven a los dermatólogos y médicos a quedarse y brindar sus servicios.
57 @BeH ea lt hP R
Por: Redacción BeHealth
Aunque no existe una manera infalible de prevenir el cáncer gástrico, se pueden tomar medidas para reducir el riesgo de desarrollarlo mediante la implementación de pequeños cambios en el estilo de vida. Además, es importante destacar que adoptar ciertas prácticas saludables puede contribuir significativamente a la disminución de las posibilidades de padecer esta enfermedad.
Estilo de vida y nutrición en el paciente con cáncer gástrico
Nutrición y actividad física
La Sociedad Americana Contra el Cáncer recomienda seguir una alimentación saludable que incluya una variedad colorida de frutas, vegetales y granos integrales. Por otro lado, sugiere limitar o evitar el consumo de carnes rojas y procesadas, bebidas endulzadas con azúcar, así como alimentos salados y ahumados.
Además, se ha observado que el consumo de alcohol probablemente incrementa el riesgo de esta enfermedad, por lo que evitar su consumo podría ser muy beneficioso.
Varias investigaciones han demostrado que los cereales integrales, los carotenoides, el té verde y las sustancias presentes en el ajo pueden reducir el riesgo de cáncer gástrico.
La práctica regular de actividad física previene numerosas enfermedades, incluido este tipo de cáncer. Intenta agregar ejercicios a tu rutina y practicarlos la mayoría de los días de la semana. Esto también te ayudará a evitar el sobrepeso u obesidad, que son factores de riesgo importantes para padecer cáncer gástrico.


Dejar de fumar
Dejar de fumar o nunca haberlo hecho disminuye el riesgo de cáncer de estómago. Aunque abandonar este hábito resulta muy difícil, será un paso a favor de tu salud.
Tratar la infección por Helicobacter pylori
Algunos estudios han sugerido que administrar antibióticos a las personas infectadas con H. pylori podría reducir el número de lesiones precancerosas en el estómago y, por lo tanto, la posibilidad de padecer cáncer gástrico.
Usar aspirina
El uso de aspirina y otros agentes antiinflamatorios no esteroideos (AINE), como naproxeno o ibuprofeno, parece reducir el riesgo de cáncer gástrico. Estos medicamentos también pueden disminuir la aparición de pólipos en el colon y cáncer de colon. Sin embargo, también pueden causar sangrado interno grave y otros riesgos potenciales para la salud en algunas personas.
Los especialistas no recomiendan tomar de manera cotidiana AINE específicamente para prevenir el
58 www.behealthoncologia.com
cáncer de estómago, ya que hasta el momento los estudios no han determinado el equilibrio entre los riesgos y beneficios de tomar este tipo de medicamentos.

Prevención en personas con riesgo elevado
El síndrome de cáncer gástrico difuso hereditario representa un pequeño porcentaje de la enfermedad a nivel mundial, pero es importante recono-
cerlo, ya que la mayoría de los pacientes que lo heredan padecen cáncer en el futuro.
Tener familiares cercanos que hayan padecido cáncer gástrico sugiere que podría haber un riesgo de desarrollar este síndrome. Debes consultar a un profesional para que te realice las pruebas genéticas pertinentes y prevenir, de manera temprana, la aparición de la enfermedad.
59 @BeH ea lt hP R
Los riñones desempeñan una función crucial en el filtrado de desechos de la sangre y la producción de orina. También ayudan a regular la presión arterial y aseguran un adecuado nivel de glóbulos rojos en el cuerpo.
Por: Redacción BeHealth
Guía para comprender el diagnóstico de cáncer de riñón

¿Cómo se origina el cáncer de riñón?


El cáncer de riñón, conocido como carcinoma de células renales, se desarrolla cuando las células de uno o ambos riñones comienzan a crecer de manera descontrolada y forman un tumor que reemplaza a las células sanas. Este tipo de cáncer se encuentra entre los diez más comunes tanto en hombres como en mujeres.
Carcinoma de células renales (CCR)
Aunque existen varios tipos de cáncer de riñón, el carcinoma de células renales (CCR) es el más común. Aproximadamente el 90% de las personas diagnosticadas con cáncer de riñón tienen este tipo específico. Por lo general, el CCR se presenta como un tumor dentro de uno de los riñones, pero también puede haber casos en los que se formen múltiples tumores en uno o ambos riñones.
¿Quién está en riesgo?
La mayoría de las personas diagnosticadas con cáncer de riñón tienen edades comprendidas
entre los 50 y 70 años. Los hombres tienen de 2 a 3 veces más probabilidades de desarrollarlo que las mujeres, y los afroamericanos tienen un mayor riesgo en comparación con otros grupos étnicos. La hipertensión, las enfermedades renales y ciertos trastornos genéticos, como la enfermedad de von Hippel-Lindau, también pueden aumentar las posibilidades de desarrollar cáncer de riñón. Además, en algunos casos, el cáncer de riñón puede tener una predisposición hereditaria. Tienes un mayor riesgo de desarrollar cáncer de riñón si:
Fumas: El hábito de fumar duplica tu riesgo. Se estima que el 30% de los casos de cáncer de riñón
60 www.behealthoncologia.com
en hombres y el 25% en mujeres están relacionados con el tabaquismo.
Tienes sobrepeso: Las personas con sobrepeso u obesidad tienen casi el doble de probabilidades de desarrollar carcinoma de células renales (CCR).
Estás expuesto a ciertas sustancias en tu lugar de trabajo, como el cadmio o el tricloroetileno. La exposición a estas sustancias puede aumentar el riesgo de cáncer de riñón.
Síntomas
Si tienes un tumor renal pequeño, es posible que no presentes ningún síntoma notable. Sin embargo, los tumores más grandes pueden causar los siguientes problemas:

Sangre en la orina
Presencia de un bulto en el costado o en la parte baja de la espalda
Dolor en la parte baja de la espalda
Sensación de cansancio o fatiga
Pérdida de peso inexplicada
Fiebre
Diagnóstico: Análisis de orina y sangre
Tu médico realizará un examen para evaluar si puedes tener cáncer de riñón. Es probable que te realicen un análisis de orina para detectar la presencia de sangre o células cancerosas en la misma. También es posible que te realicen un análisis de sangre para evaluar la función de tus riñones y obtener un hemograma completo, que incluye la evaluación de tus niveles de glóbulos blancos, glóbulos rojos y plaquetas. Las personas con cáncer de riñón suelen presentar anemia, que se caracteriza por una disminución en la cantidad de glóbulos rojos en el organismo.
DIAGNÓSTICO
Pruebas de imagen Para obtener una visión más detallada de los riñones, el médico puede realizar diferentes tipos de exploraciones:
Ecografía: Se utilizan ondas sonoras para producir imágenes en blanco y negro en una pantalla de ordenador.
Tomografía computarizada (TC): Se obtienen imágenes más completas al combinar radiografías tomadas desde diferentes ángulos.
Resonancia magnética (RM): Se utilizan imanes y ondas de radio para obtener imágenes detalladas.
Tomografía por emisión de positrones (PET): Se crean imágenes tridimensionales en color mediante radiación.
BIOPSIA
En casos poco frecuentes se puede realizar una biopsia para obtener una muestra pequeña del tumor y analizarla. Sin embargo, en el cáncer de riñón, las biopsias rara vez son necesarias. Si el médico determina que se requiere una biopsia, se
61 @BeH ea lt hP R
realizará una intervención quirúrgica para tomar la muestra con una aguja. La biopsia permitirá confirmar si el tumor es canceroso.
CATEGORÍAS Y ETAPAS
Si se diagnostica cáncer de riñón, el médico intentará determinar la rapidez de crecimiento del tumor, basándose en el aspecto de las células cancerosas en comparación con las células sanas. El cáncer de riñón puede clasificarse en grados del 1 al 4, siendo las células de grado 4 las que presentan un aspecto más diferente y tienden a crecer más rápidamente.
Además, el médico tratará de determinar el grado de propagación del cáncer, clasificándolo en estadios del I al IV. El cáncer en estadio I se encuentra únicamente en el riñón, mientras que el cáncer en estadio IV se ha extendido a otras partes del cuerpo.
PLAN DE TRATAMIENTO
El médico te recomendará un plan de tratamiento basado en el tipo de cáncer de riñón, su grado y estadio, tu edad y cualquier otro problema de salud que puedas tener.
Opciones de tratamiento:
Cirugía: Es el tratamiento más común. Puede implicar la extirpación del tumor y preservar la parte sana del riñón, o en algunos casos, la extirpación completa del riñón. La mayoría de las personas se recuperan bien con un solo riñón.
Terapia dirigida: Se utilizan fármacos que atacan los vasos sanguíneos que alimentan el tumor, impidiendo su crecimiento. También existen terapias dirigidas que bloquean una proteína llamada mTOR, que contribuye al crecimiento de las células cancerosas.
Inmunoterapia: Consiste en fortalecer el sistema inmunológico para que pueda combatir y destruir las células cancerosas. Puede ser recomendada si la terapia dirigida no es efectiva, o en algunos casos, se combinan ambas terapias.
Quimioterapia: Se utiliza una combinación de fármacos para destruir las células cancerosas que se dividen rápidamente. Aunque no es muy efectiva contra el cáncer de riñón, puede ser considerada si otros tratamientos no han funcionado.
Radioterapia: Se emplean rayos de alta energía para destruir las células cancerosas o reducir el tamaño de los tumores. Sin embargo, el cáncer de riñón no es muy sensible a la radiación, por lo que no se utiliza con frecuencia. Se puede considerar en casos en los que no es posible realizar una cirugía o para aliviar síntomas como el dolor o la hemorragia. También puede administrarse si el cáncer se ha propagado a otras partes del cuerpo, como los huesos o el cerebro.
Ensayos clínicos: Los investigadores están trabajando para encontrar nuevos tratamientos. Si se presenta voluntario para participar en un ensayo clínico podrá recibir un tratamiento de vanguardia años antes que otras personas.
62
www.behealthoncologia.com
Cáncer de Riñón: Aprendiendo a identificar las señales
El cáncer de riñón puede permanecer silencioso durante mucho tiempo y el 20% de los casos muestra síntomas únicamente cuando ya se encuentra en una etapa avanzada.
Algunos de los síntomas más comunes son: #CáncerDeRiñón
Sangre en la orina (hematuria)
Dolor persistente en un lado de la espalda
Masa palpable en el costado o espalda baja
Hinchazón de los tobillos y piernas
Pérdida de peso progresiva
Pérdida del apetito
Cansancio excesivo
En los hombres, el desarrollo de venas agrandadas, conocido como varicocele, alrededor de un testículo, en especial el derecho
63 @BeH ea lt hP R
Anemia Fiebre leve o alta Presión arterial alta 1 2 3 4 5 6 7 8 9 10 11
Por: Redacción BeHealth
El cáncer de hígado es una enfermedad grave que afecta a un órgano vital del cuerpo humano: el hígado. Esta forma de cáncer se caracteriza por el crecimiento anormal y descontrolado de células malignas en el tejido hepático. A medida que avanza, puede comprometer la función del hígado y propagarse a otras partes del cuerpo.
Alternativas terapéuticas para el manejo y control del cáncer de hígado
¿Cómo se diagnostica? Existen varios exámenes y procedimientos utilizados para diagnosticar el cáncer de hígado. Estos incluyen:
Análisis de sangre : Los análisis de sangre pueden revelar anomalías en la función hepática, como niveles elevados de enzimas hepáticas y marcadores tumorales asociados al cáncer de hígado.


Pruebas de diagnóstico por imágenes: El médico puede recomendar pruebas de diagnóstico por imágenes, como una ecografía abdominal, una tomografía computarizada (TC) o una resonancia magnética (RM). Estas pruebas permiten obtener imágenes detalladas del hígado y evaluar cualquier masa o lesión sospechosa.
Biopsia hepática: En algunos casos, es necesario extraer una muestra de tejido hepático para realizar análisis en el laboratorio y obtener un diagnóstico definitivo de cáncer de hígado. Durante una biopsia hepática, el médico inserta una aguja delgada a través de la piel y dentro del hígado para obtener una muestra de tejido. El tejido se examina bajo un microscopio en



busca de células cancerosas. Es importante tener en cuenta que la biopsia hepática conlleva un pequeño riesgo de complicaciones, como hemorragia, moretones o infección.
Estos exámenes y procedimientos son fundamentales para confirmar la presencia de cáncer de hígado, evaluar su etapa y determinar las opciones de tratamiento más adecuadas para cada paciente.
Determinación del estadio del cáncer de hígado Una vez que se realiza el diagnóstico de cáncer de hígado, el médico se enfoca en determinar el grado o estadio de la enfermedad. Las pruebas
64
www.behealthoncologia.com
de estadio son fundamentales para evaluar el tamaño y la ubicación del cáncer, así como para determinar si se ha propagado a otras áreas del cuerpo. Las pruebas de imagen, como tomografías computarizadas, resonancias magnéticas y gammagrafías óseas, son utilizadas para clasificar el cáncer de hígado.
Existen diferentes métodos para clasificar las etapas del cáncer de hígado. Algunos utilizan números romanos del I al IV, mientras que otros emplean letras de la A a la D. Estos sistemas de clasificación permiten al médico determinar el estadio exacto del cáncer, lo cual es crucial para establecer las opciones de tratamiento adecuadas y brindar un pronóstico estimado.
Tratamiento
Los tratamientos para el cáncer de hígado primario varían según la etapa de la enfermedad, la edad, la salud general y las preferencias personales del paciente.
Cirugía
Uno de los enfoques de tratamiento es la cirugía, que puede incluir la extracción del tumor y una porción pequeña de tejido hepático sano que lo rodea. Sin embargo, esta opción depende del tamaño y la ubicación del cáncer dentro del hígado, así como de la función hepática y la salud general del paciente. En algunos casos de cáncer

de hígado en estadio temprano, el trasplante de hígado puede ser una opción, pero es aplicable solo a un pequeño porcentaje de personas.
Tratamientos localizados
Los tratamientos localizados se dirigen directamente a las células cancerosas o al área circundante. Estos pueden incluir la ablación por radiofrecuencia, que utiliza calor para destruir las células cancerosas, o la crioablación, que utiliza frío extremo. También se puede inyectar alcohol o medicamentos de quimioterapia en el tumor, o colocar cunetas llenas de radiación en el hígado para administrar radiación directamente al tumor.
Radioterapia
La radioterapia, mediante el uso de energía de alta potencia, como rayos X y protones, se emplea para destruir las células cancerosas y reducir los tumores. Se utiliza principalmente cuando otros tratamientos no son posibles o han sido ineficaces.

Terapia con fármacos dirigidos
La terapia con fármacos dirigidos se enfoca en anomalías específicas presentes en las células cancerosas, bloqueándolas y provocando la muerte de las células cancerosas. Además, la inmunoterapia estimula el sistema inmunológico del cuerpo para que combata el cáncer, y la quimioterapia utiliza medicamentos para destruir las células cancerosas de rápido crecimiento.
Cuidados de apoyo (paliativos)
Los cuidados paliativos también desempeñan un papel importante en el manejo del cáncer de hígado. Estos cuidados se centran en proporcionar alivio del dolor y otros síntomas, mejorando la calidad de vida del paciente y brindando apoyo adicional. El equipo de cuidados paliativos trabaja en conjunto con otros profesionales médicos para ofrecer una atención integral.
65 @BeH ea lt hP R
El cáncer uterino se conoce como un descontrol a nivel del crecimiento de las células en el área del cuello uterino. Este surge como consecuencia del contagio del virus del papiloma humano (VPH), que se transmite por contacto sexual.
Por: Redacción BeHealth
Cáncer de tiroides: ¿cómo prevenirlo?
Los tumores de tiroides se dividen principalmente en dos tipos: tumores epiteliales y tumores no epiteliales, siendo los primeros los más comunes con gran diferencia.
En cualquier caso, estos tumores se originan a partir del crecimiento anormal de células en la glándula tiroides, una estructura con forma de mariposa ubicada en la base del cuello.
¿Qué es la tiroides?
La glándula tiroides se ubica justo debajo de la nuez de Adán y consta de dos alas a cada lado de la laringe, conocidas como lóbulos. Estos lóbulos están conectados por una parte central llamada istmo. La tiroides es una glándula endocrina encargada de producir hormonas que regulan el metabolismo.
Sin embargo, la tiroides solo puede desempeñar esta función vital cuando es estimulada por la hormona TSH (hormona estimulante de la tiroides), que es secretada por la glándula pituitaria ubicada en la parte más profunda del cerebro. Dentro de las hormonas tiroideas, se encuentran moléculas de yodo, un elemento esencial para el correcto funcionamiento de la tiroides.
Cuando la tiroides presenta problemas, puede haber una deficiencia de hormonas (hipotiroidismo) o una producción excesiva de las mismas (hipertiroidismo).
Clasificación de los cánceres de tiroides Como se mencionó anteriormente, las neoplasias tiroideas se pueden clasificar en dos categorías principales: las de origen epitelial y las de origen no epitelial. En el grupo de las neoplasias epiteliales se incluyen el carcinoma folicular, el carcinoma medular y el carcinoma indiferenciado. Por otro lado, el grupo de las neoplasias no epiteliales engloba el sarcoma, el hemangioendotelioma, el linfoma y las metástasis.
El carcinoma papilar es la forma de cáncer tiroideo más común y generalmente presenta un comportamiento menos agresivo. Por otro lado, existe una forma muy agresiva pero poco frecuente denominada carcinoma anaplásico de la glándula tiroides, que tiende a producir metástasis a distancia de manera temprana.
66 www.behealthoncologia.com
Prevención
Para prevenir los tumores de tiroides, es importante seguir algunas recomendaciones relacionadas principalmente con el consumo de yodo. En una dieta con bajo aporte de yodo, se recomienda utilizar sal yodada. Es especialmente importante que las personas mayores de 45 años acudan al médico al menos una vez al año para evaluar el tamaño de la glándula tiroides.

En los países desarrollados, la falta de yodo no es muy común debido a que suele agregarse a la sal de mesa. Sin embargo, en otras regiones del mundo, especialmente en áreas sin acceso al mar y donde el consumo de pescado y mariscos frescos, ricos en yodo, es limitado, la deficiencia de yodo puede aumentar el riesgo de cáncer de tiroides.
La tiroides requiere un suministro constante de yodo para funcionar correctamente y producir hormonas como la tiroxina.
La deficiencia de yodo puede causar inicialmente la hinchazón de la tiroides, conocida como bocio, y cuando se vuelve crónica a largo plazo, aumenta la formación de nódulos y el riesgo de cáncer.
Si evita consumir sal de mesa debido a la hipertensión arterial crónica, es importante incluir regularmente pescado/mariscos en su dieta o considerar tomar suplementos de yodo.
COMPRENDER LOS TÉRMINOS CLÍNICOS
TE PERMITE CONOCER



MUCHOS DETALLES DE TU CONDICIÓN.
Accede a nuestro glosario y edúcate para que puedas tratar adecuadamente tu enfermedad.


¡Escanéa el código y edúcate con BeHealth!





 Por: Jessica López Santiago RN, MSN, CON, BCCN Enfermera Oncóloga
Por: Jessica López Santiago RN, MSN, CON, BCCN Enfermera Oncóloga

Por: Redacción BeHealth
Por: Redacción BeHealth






















 Cristian Rodríguez Hematólogo-Oncólogo
Cristian Rodríguez Hematólogo-Oncólogo
























